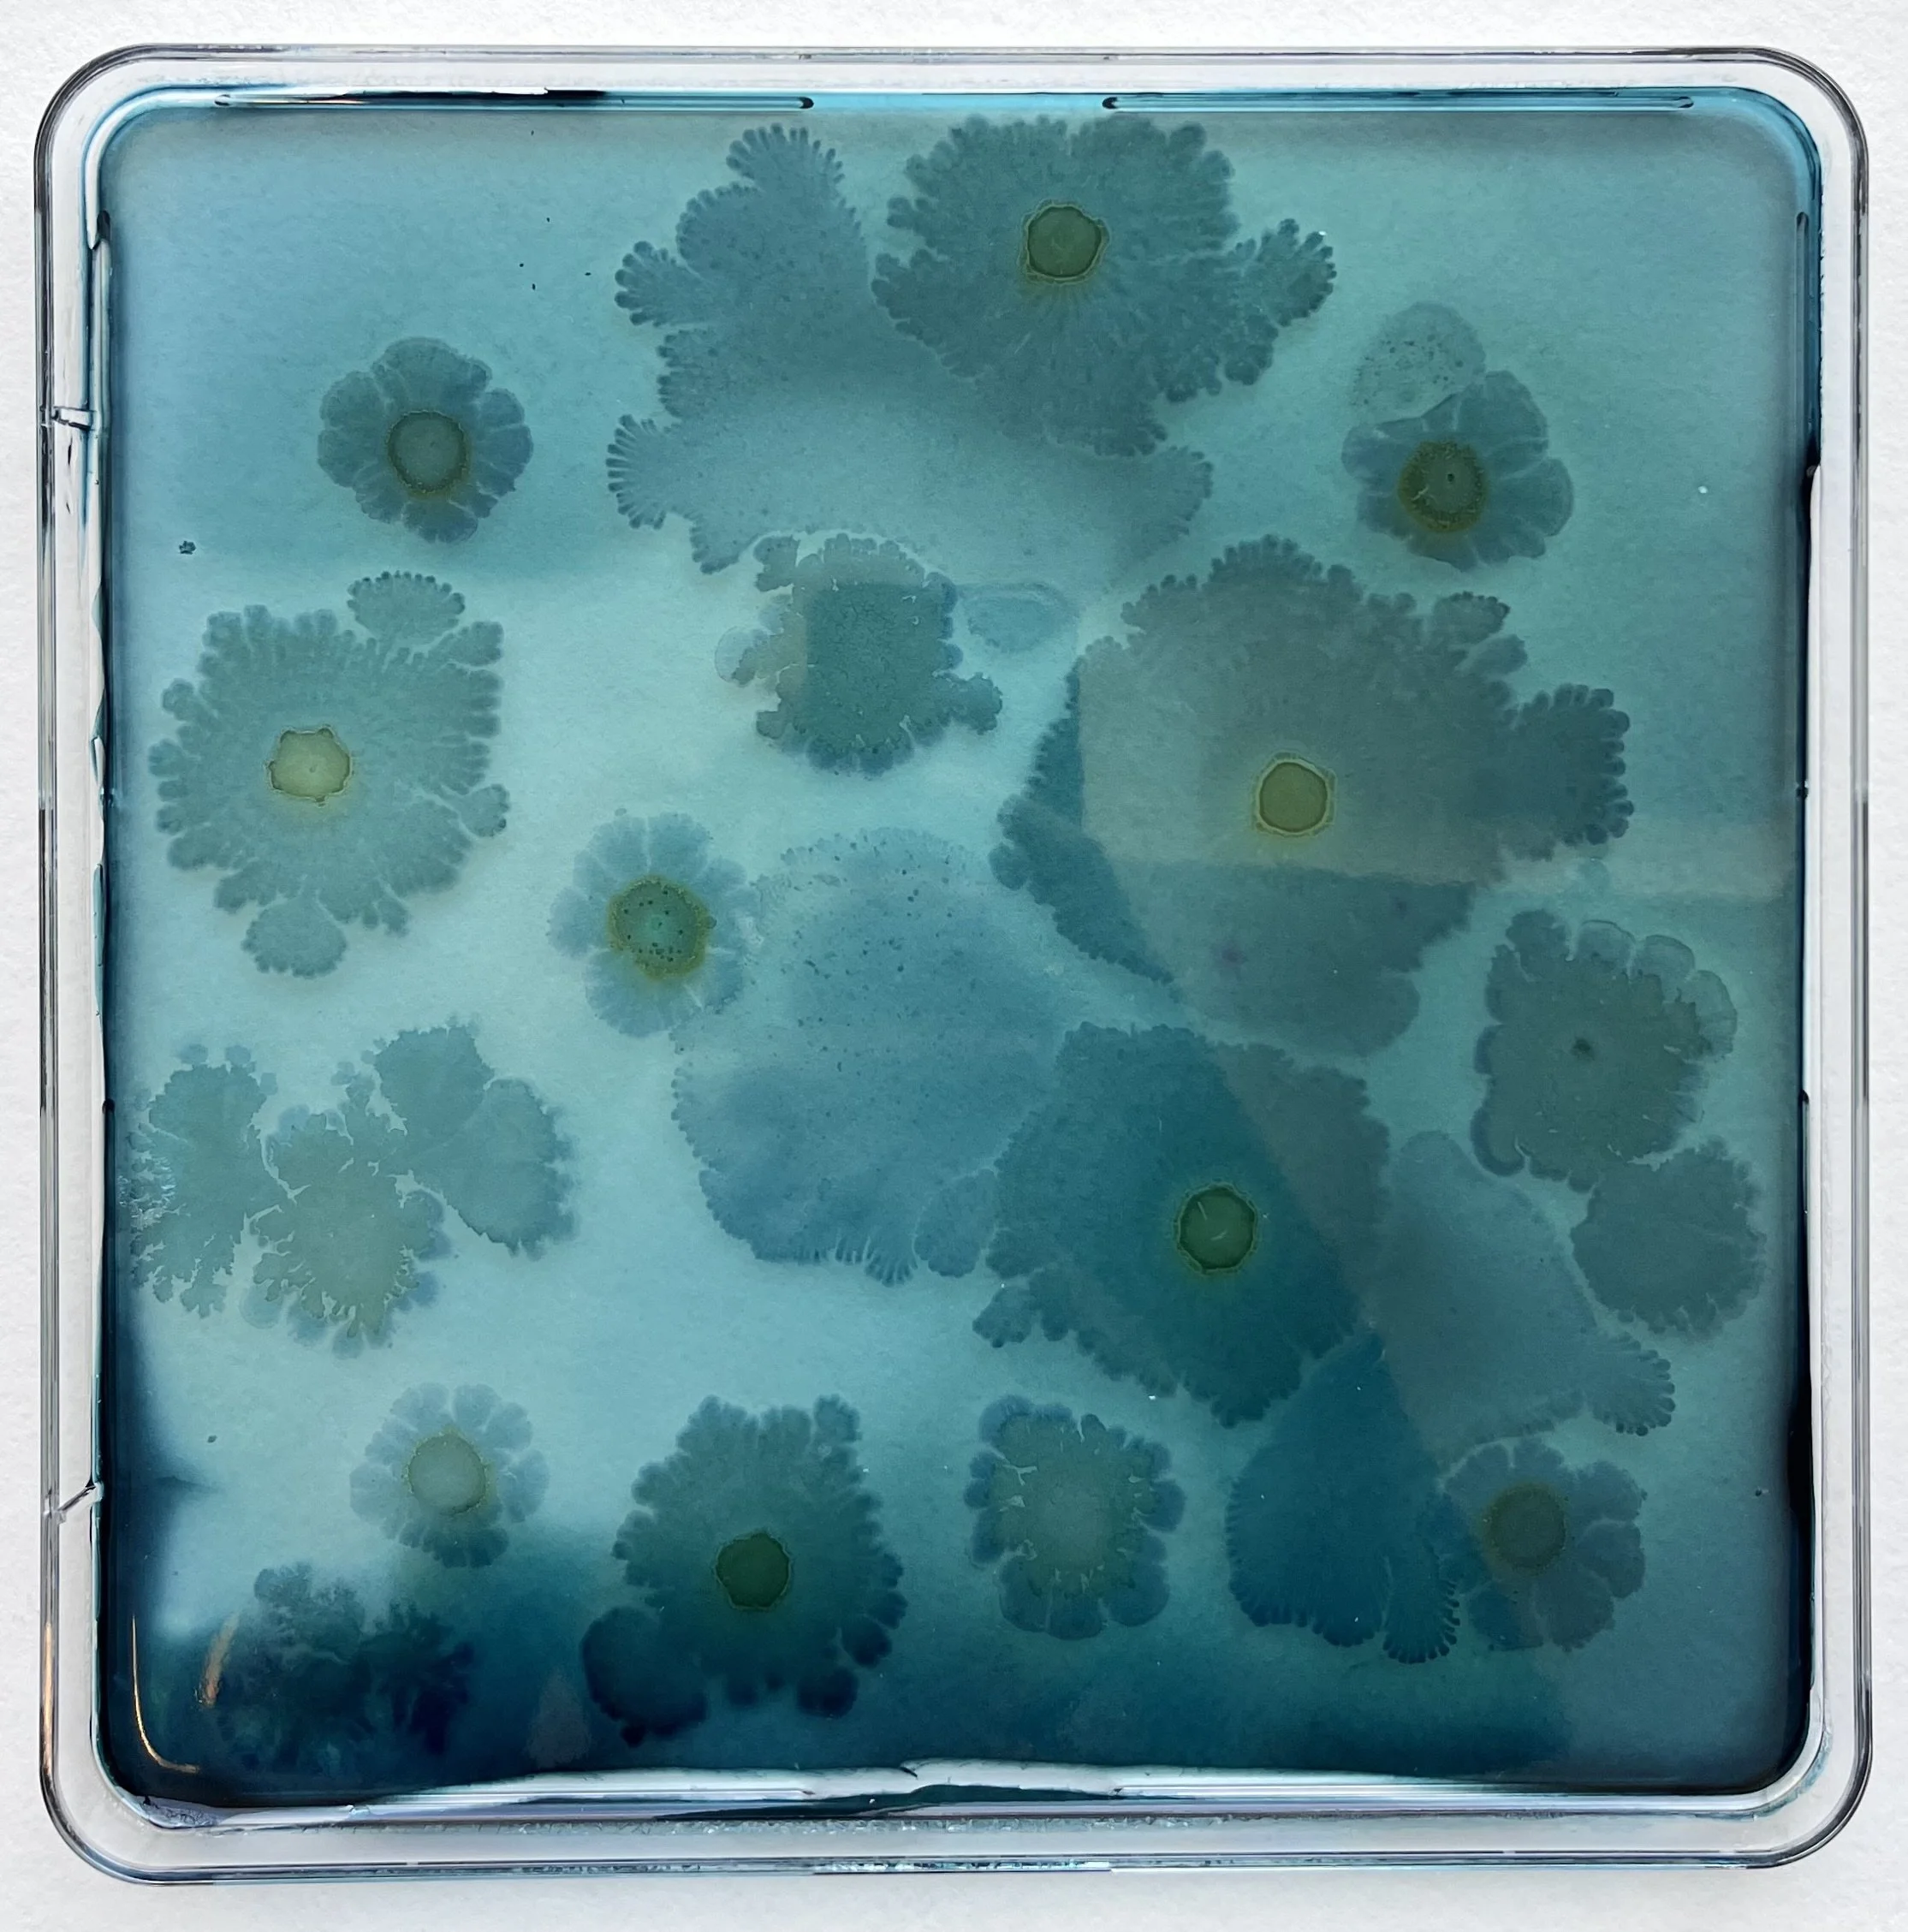
f4.1+f1.5+1.4.jpeg
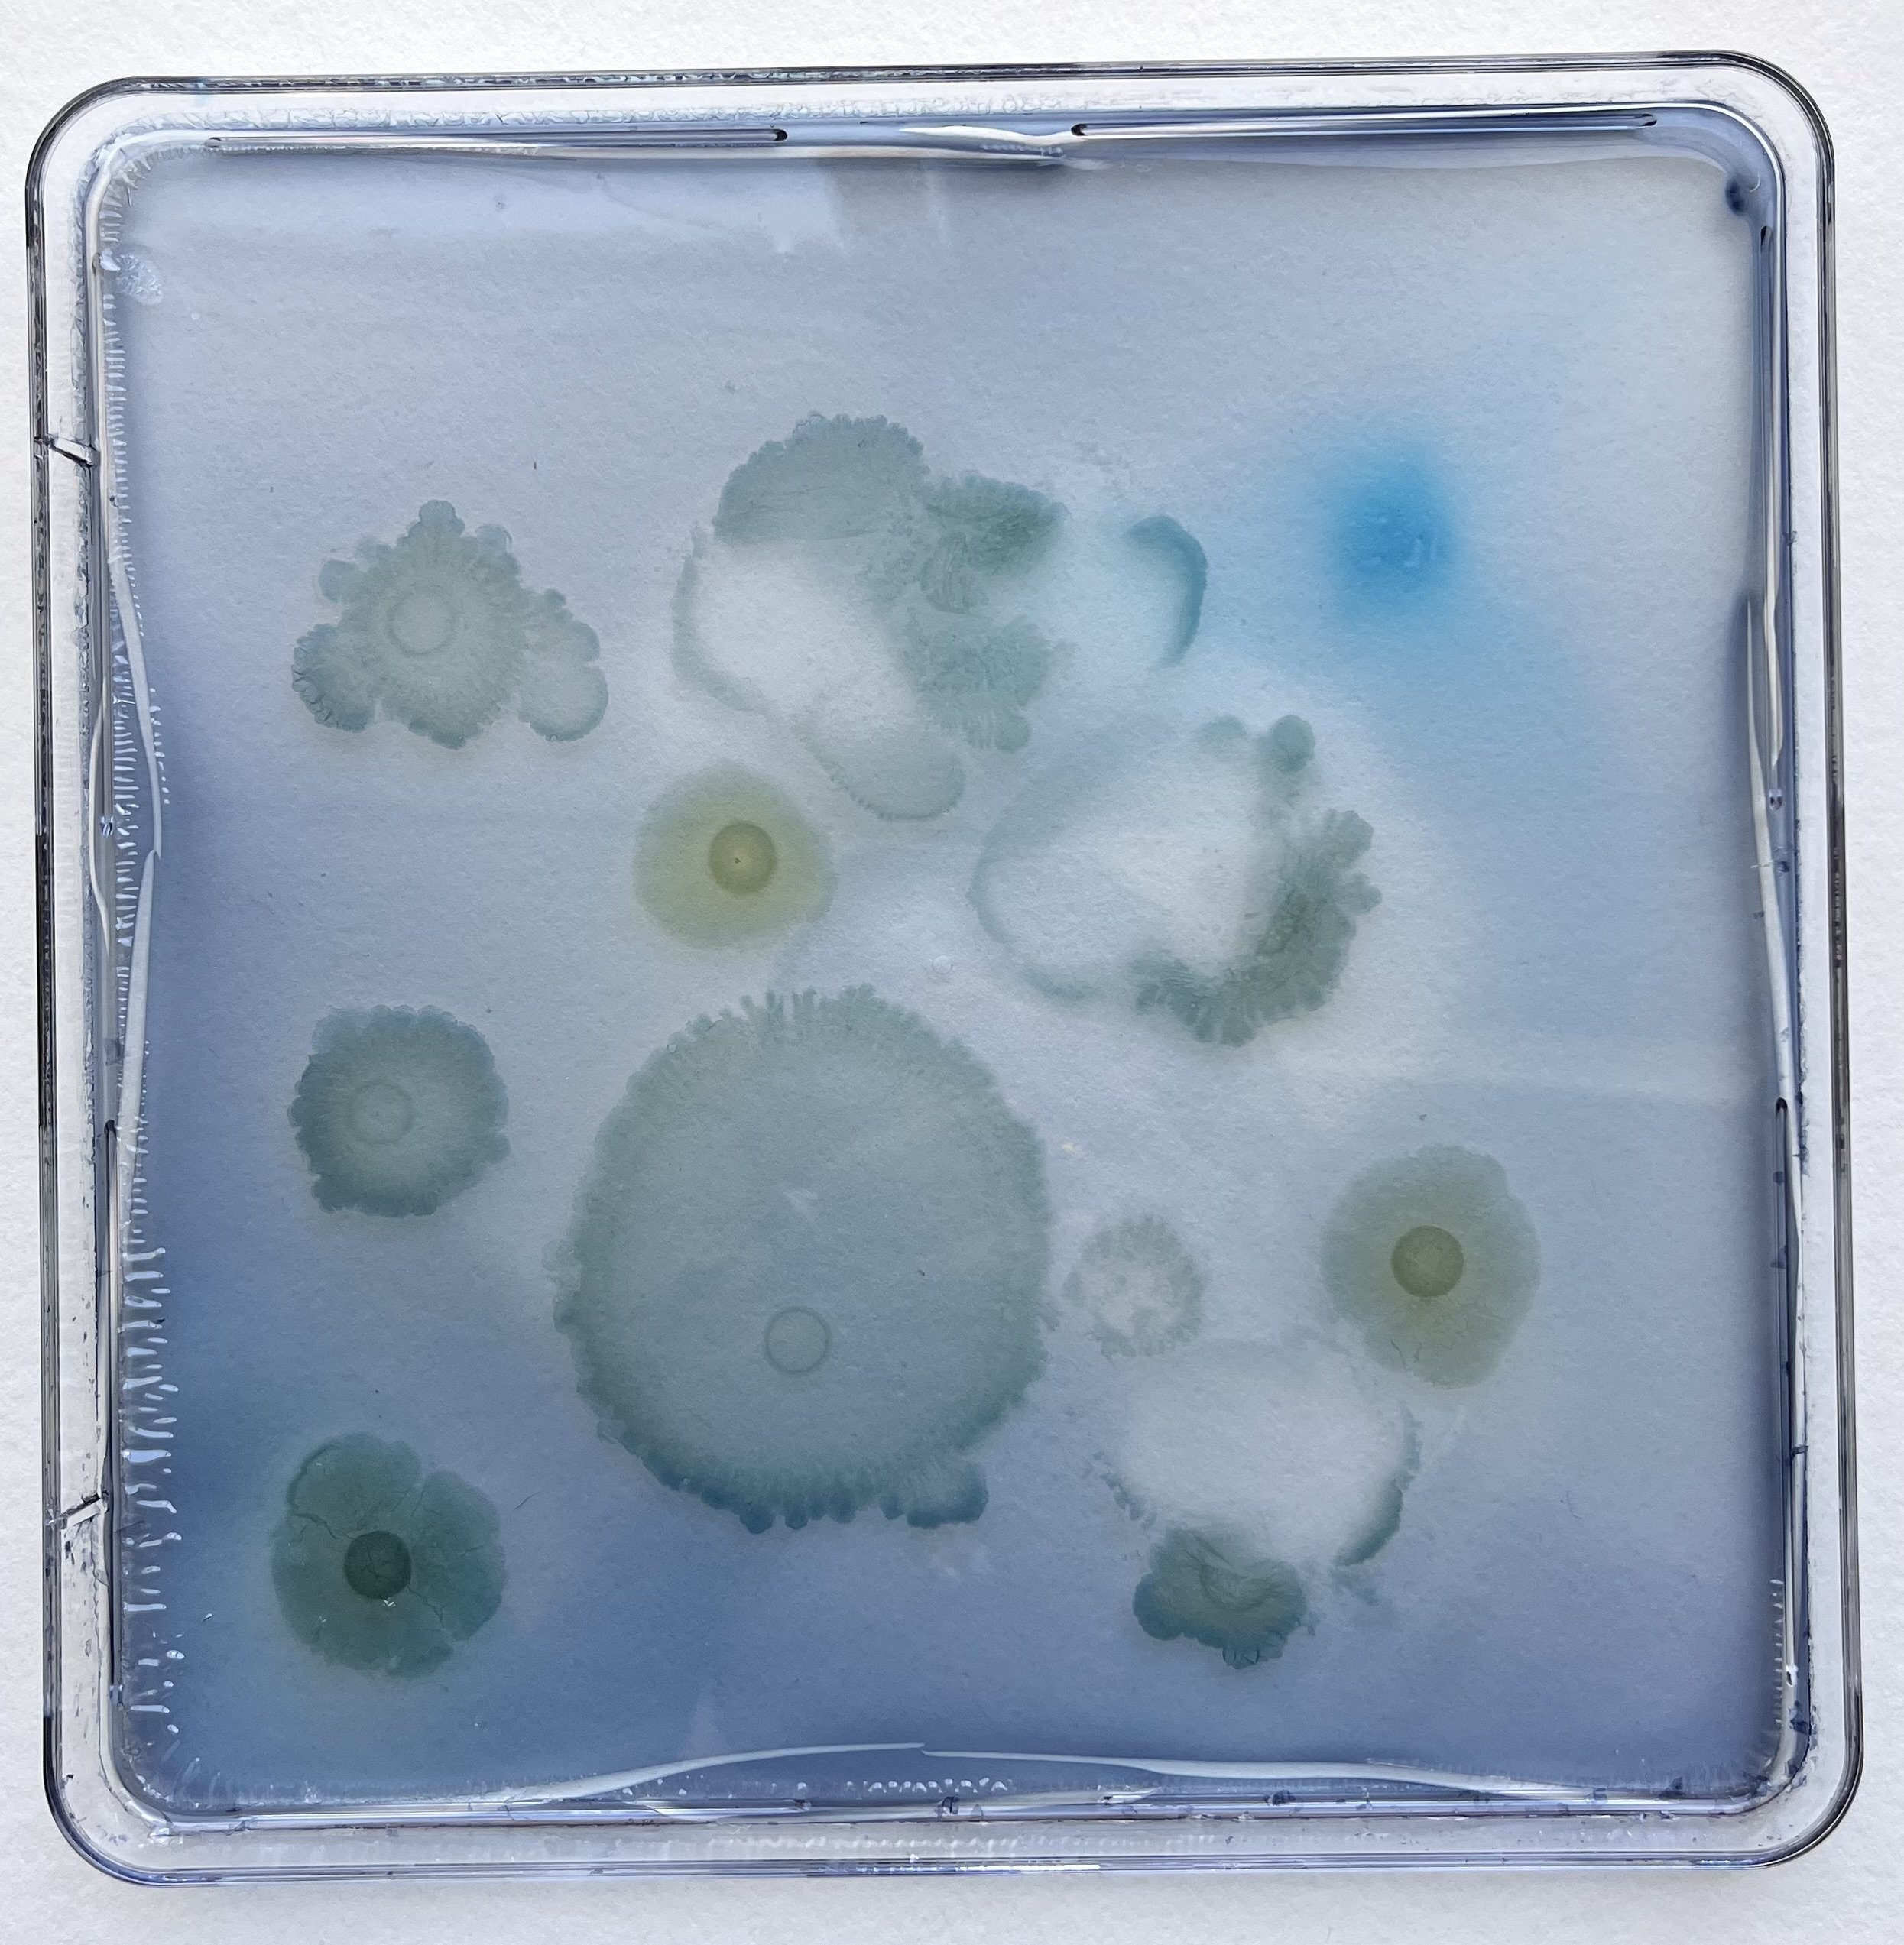
f1.2+f1.5+f2.7.jpeg
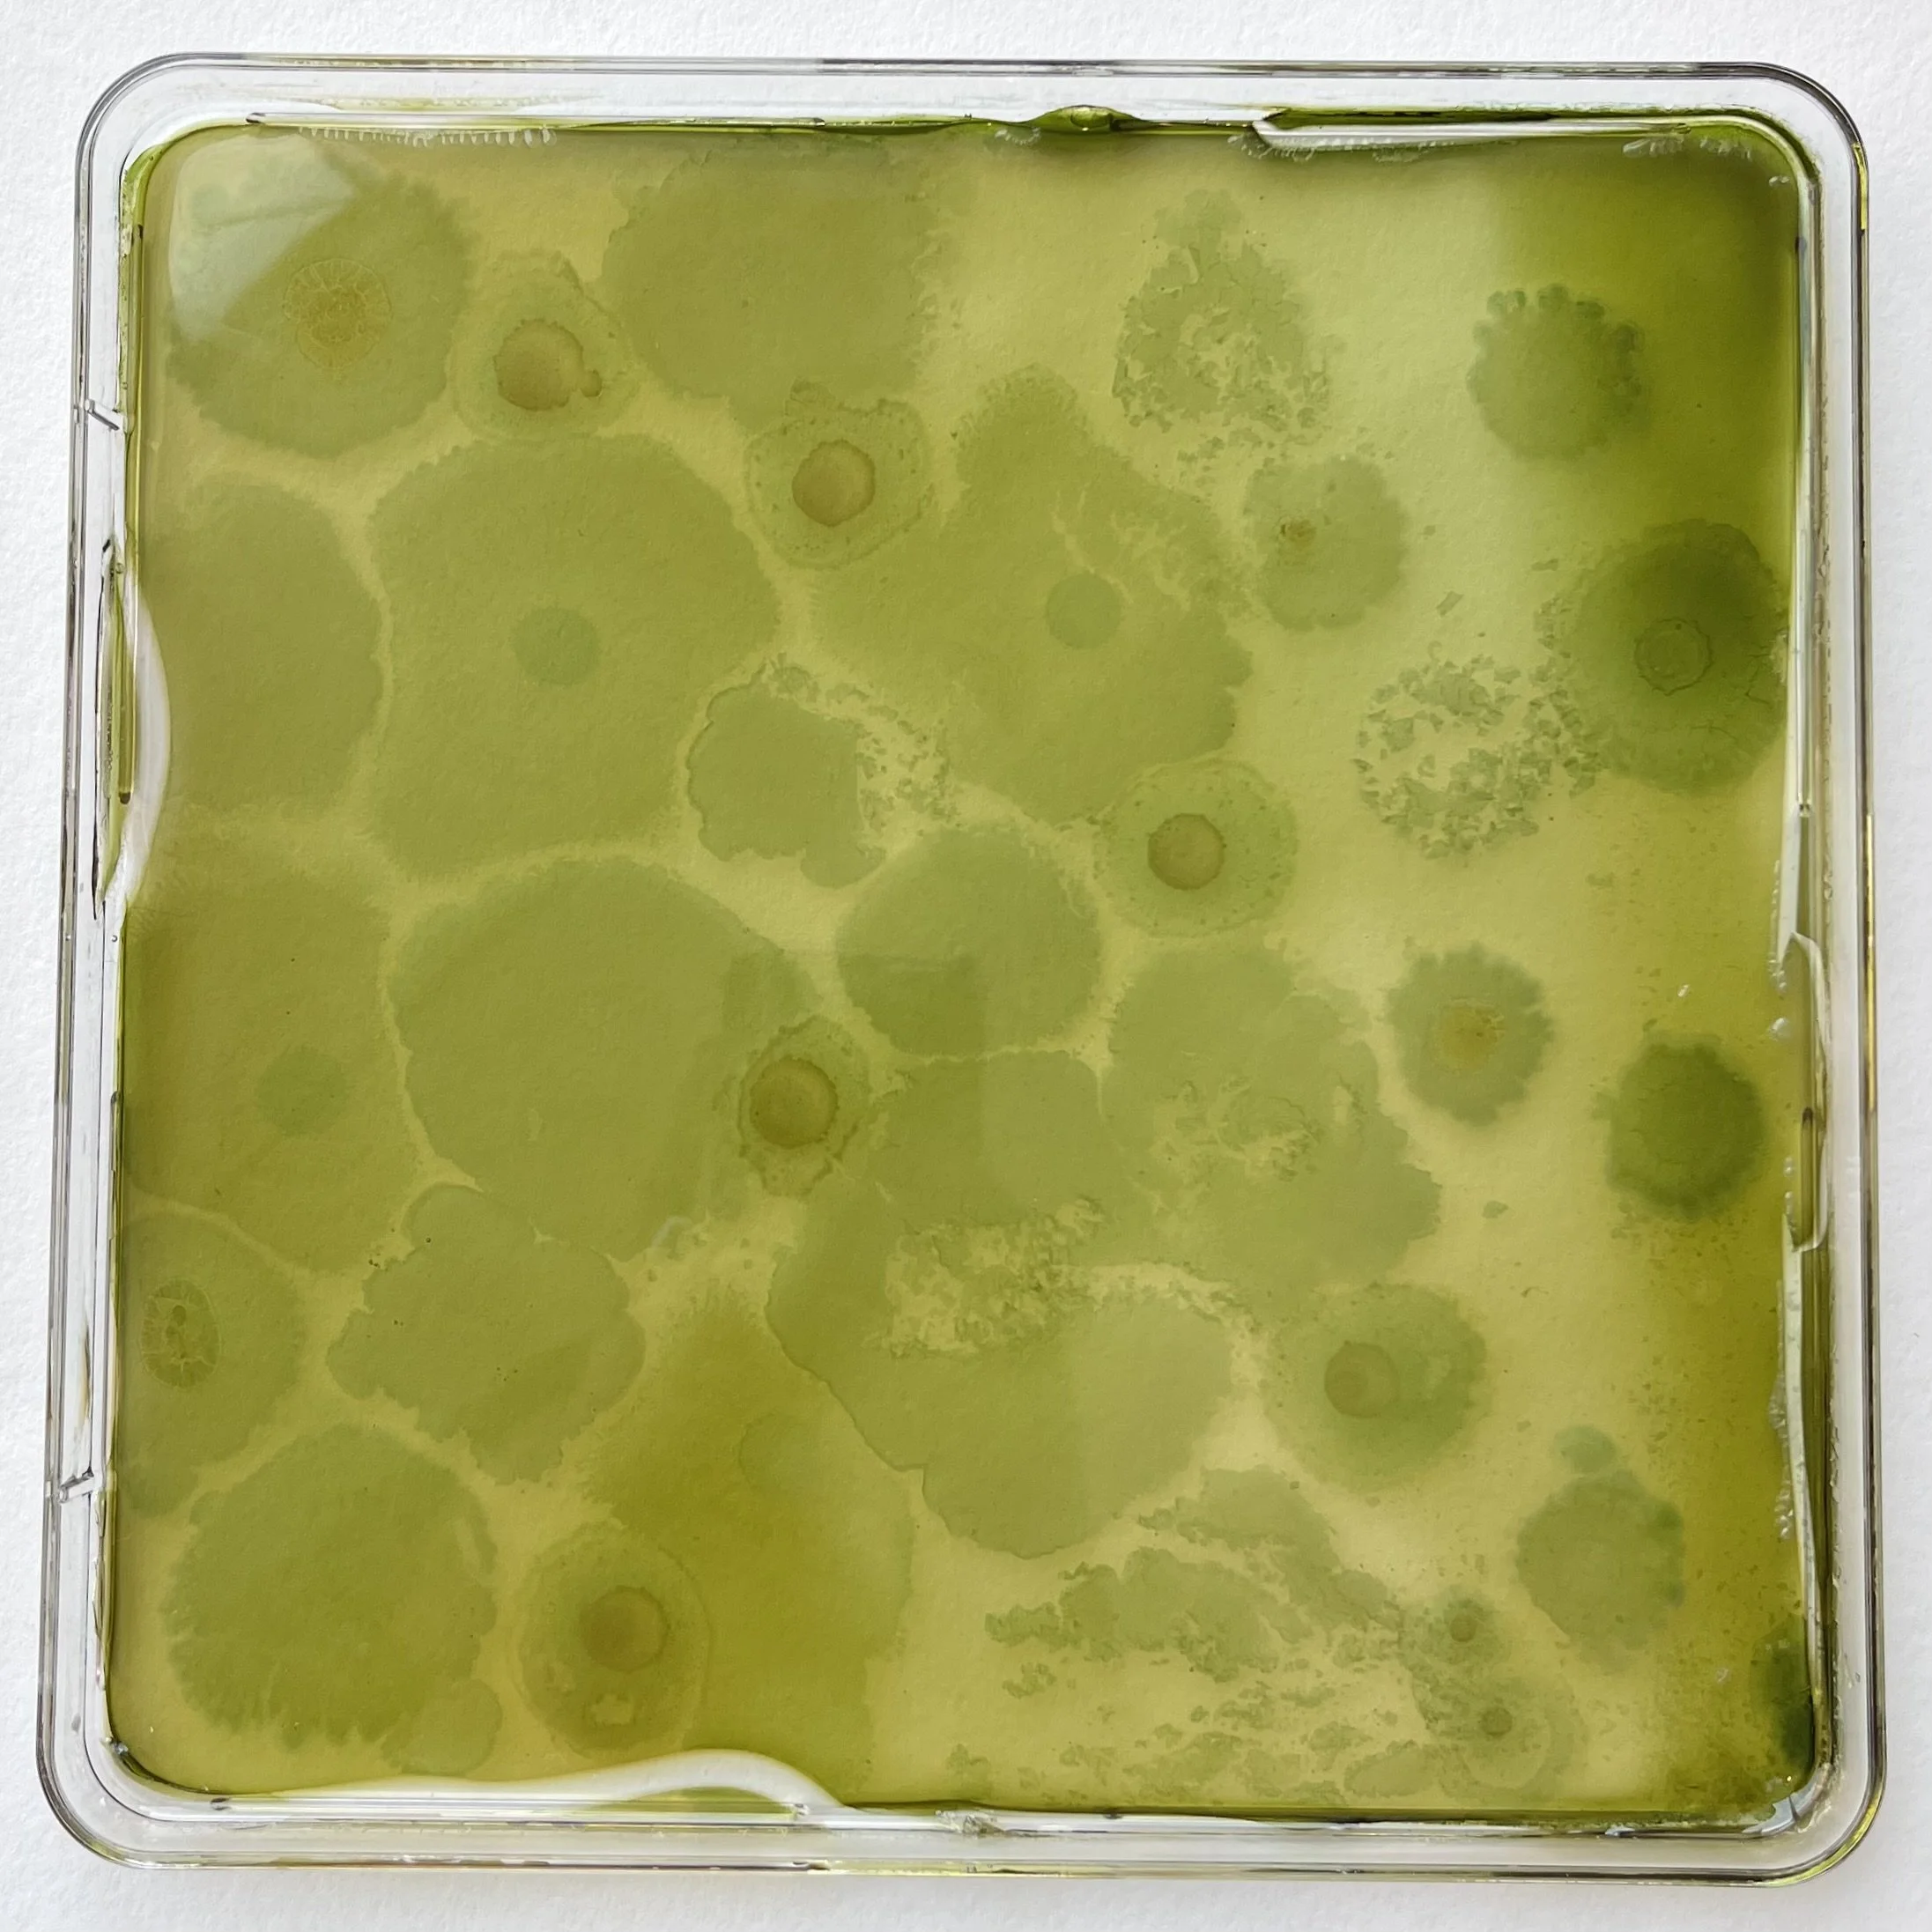
f4.1+f1.1+f2.7+f1.5+f2.2.jpeg
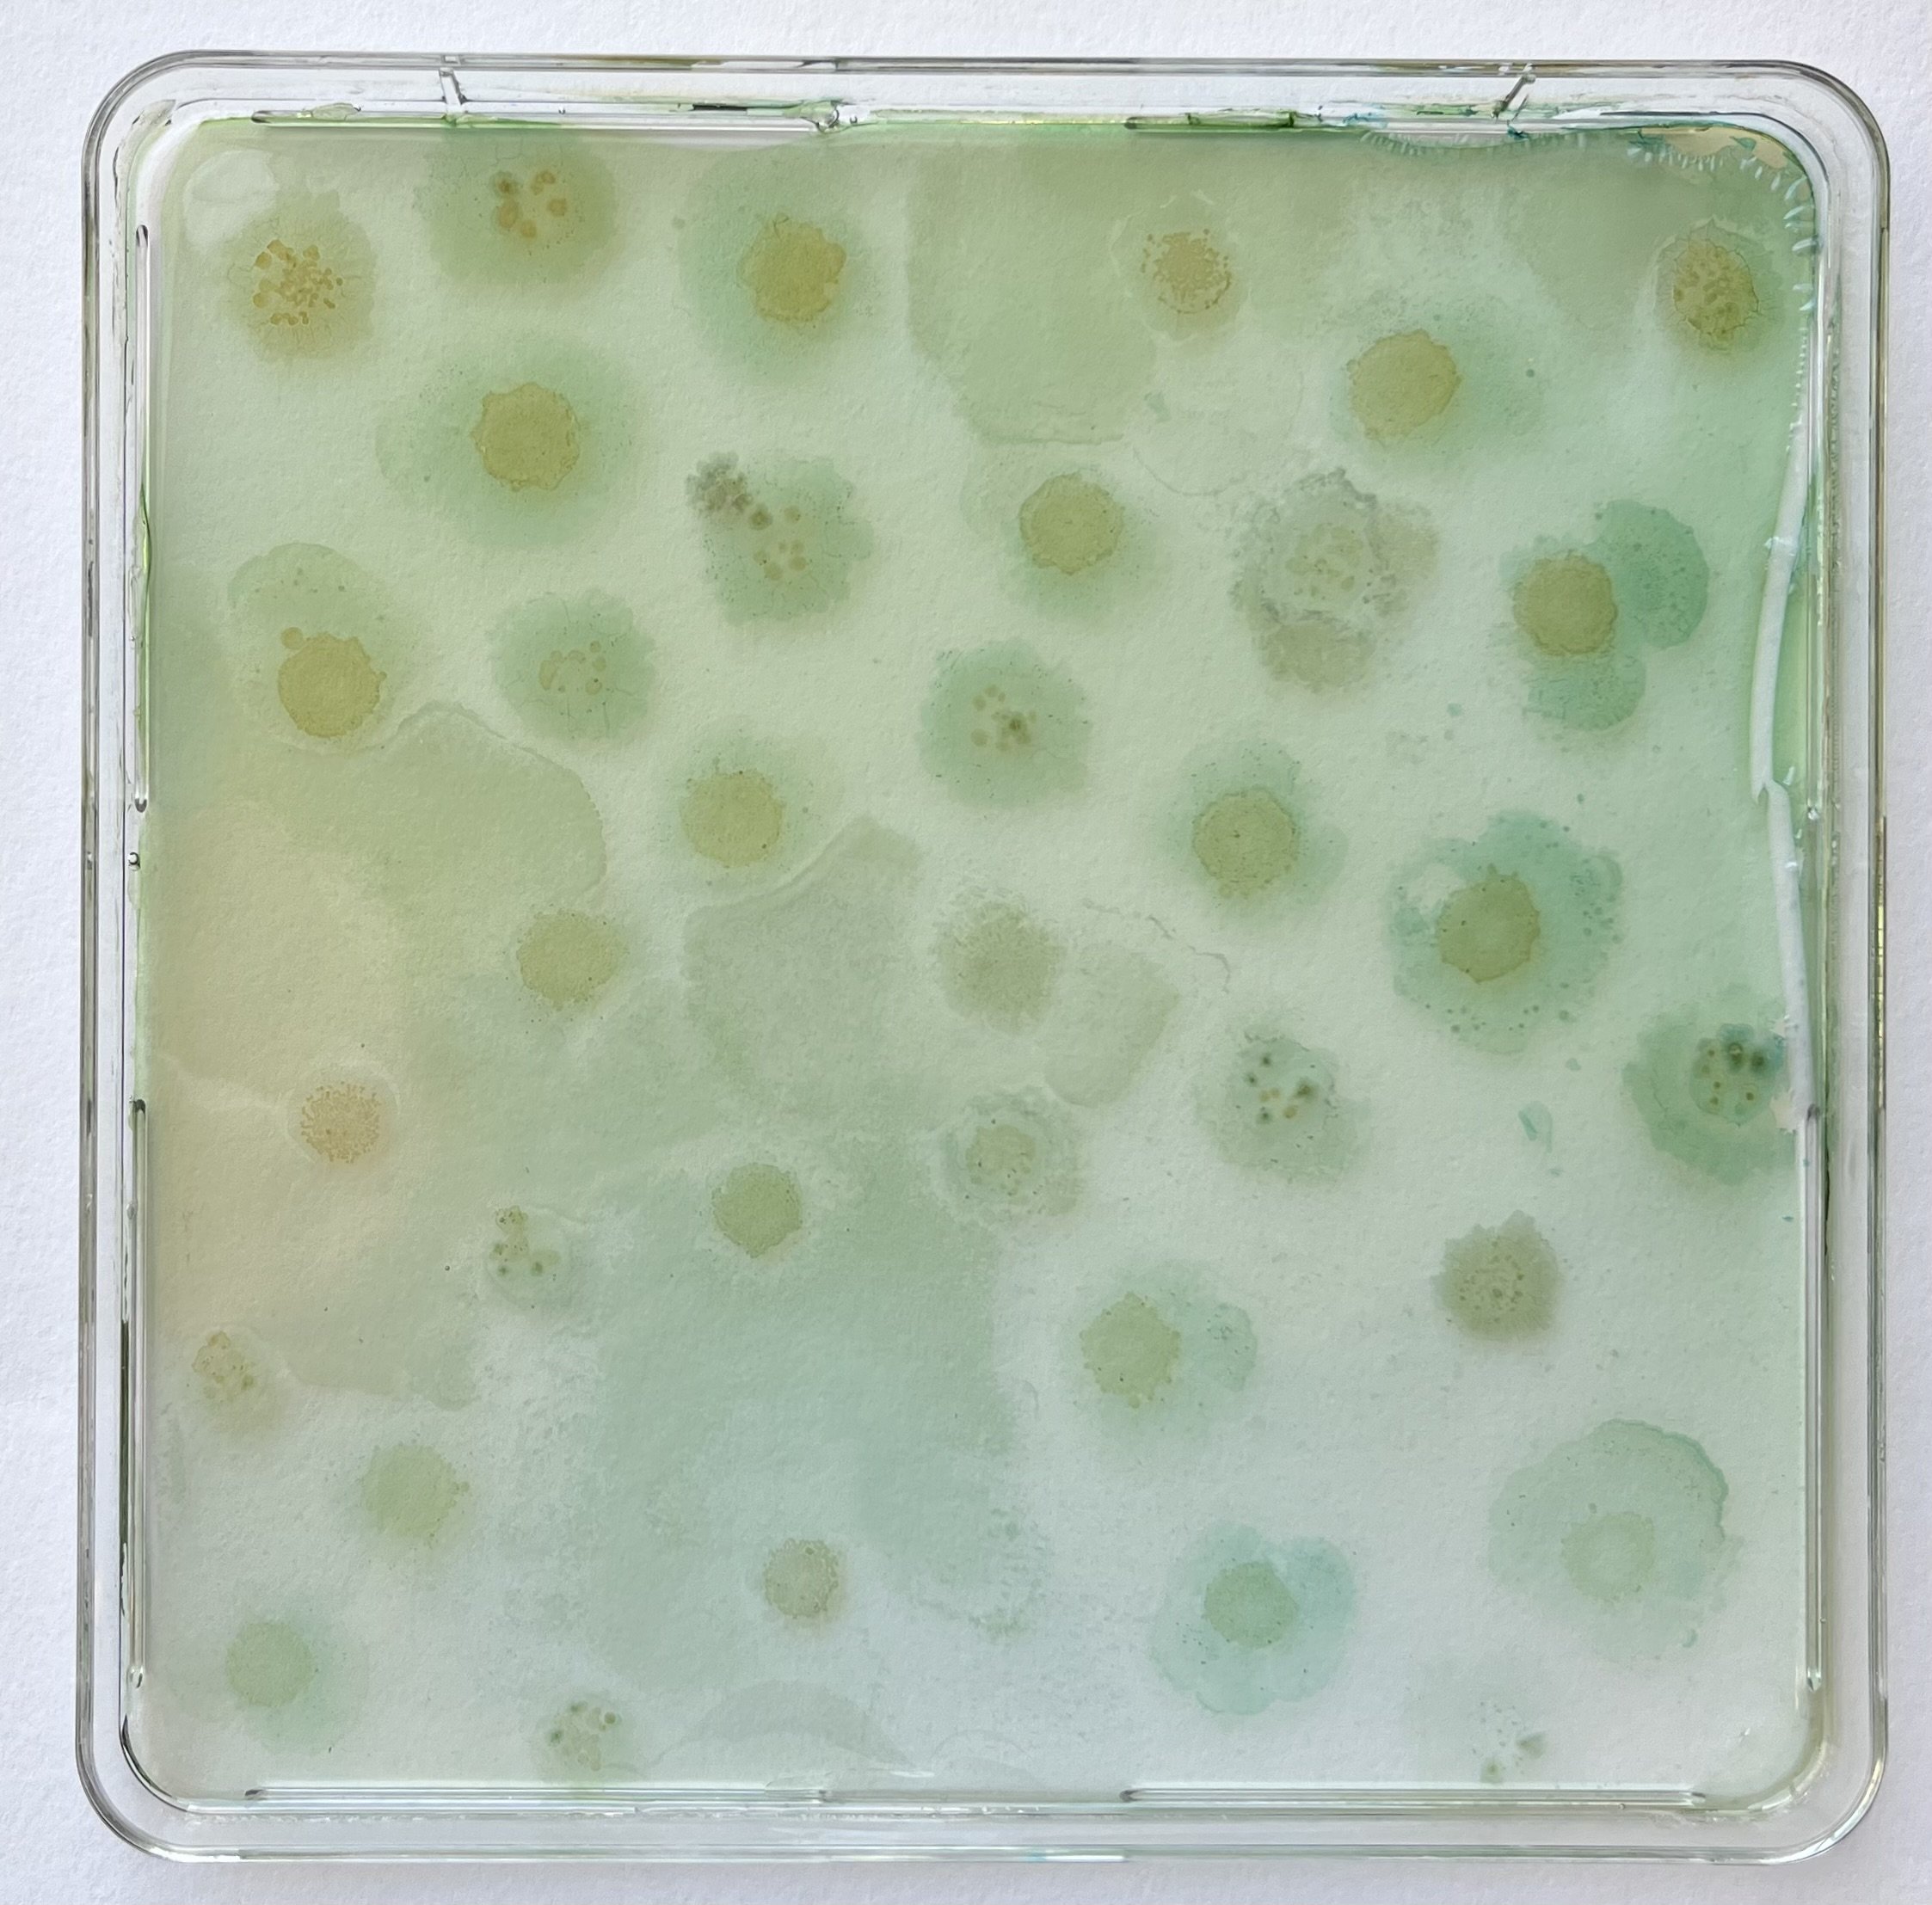
t4.4+t3.5+t2.1+t2.3.jpeg
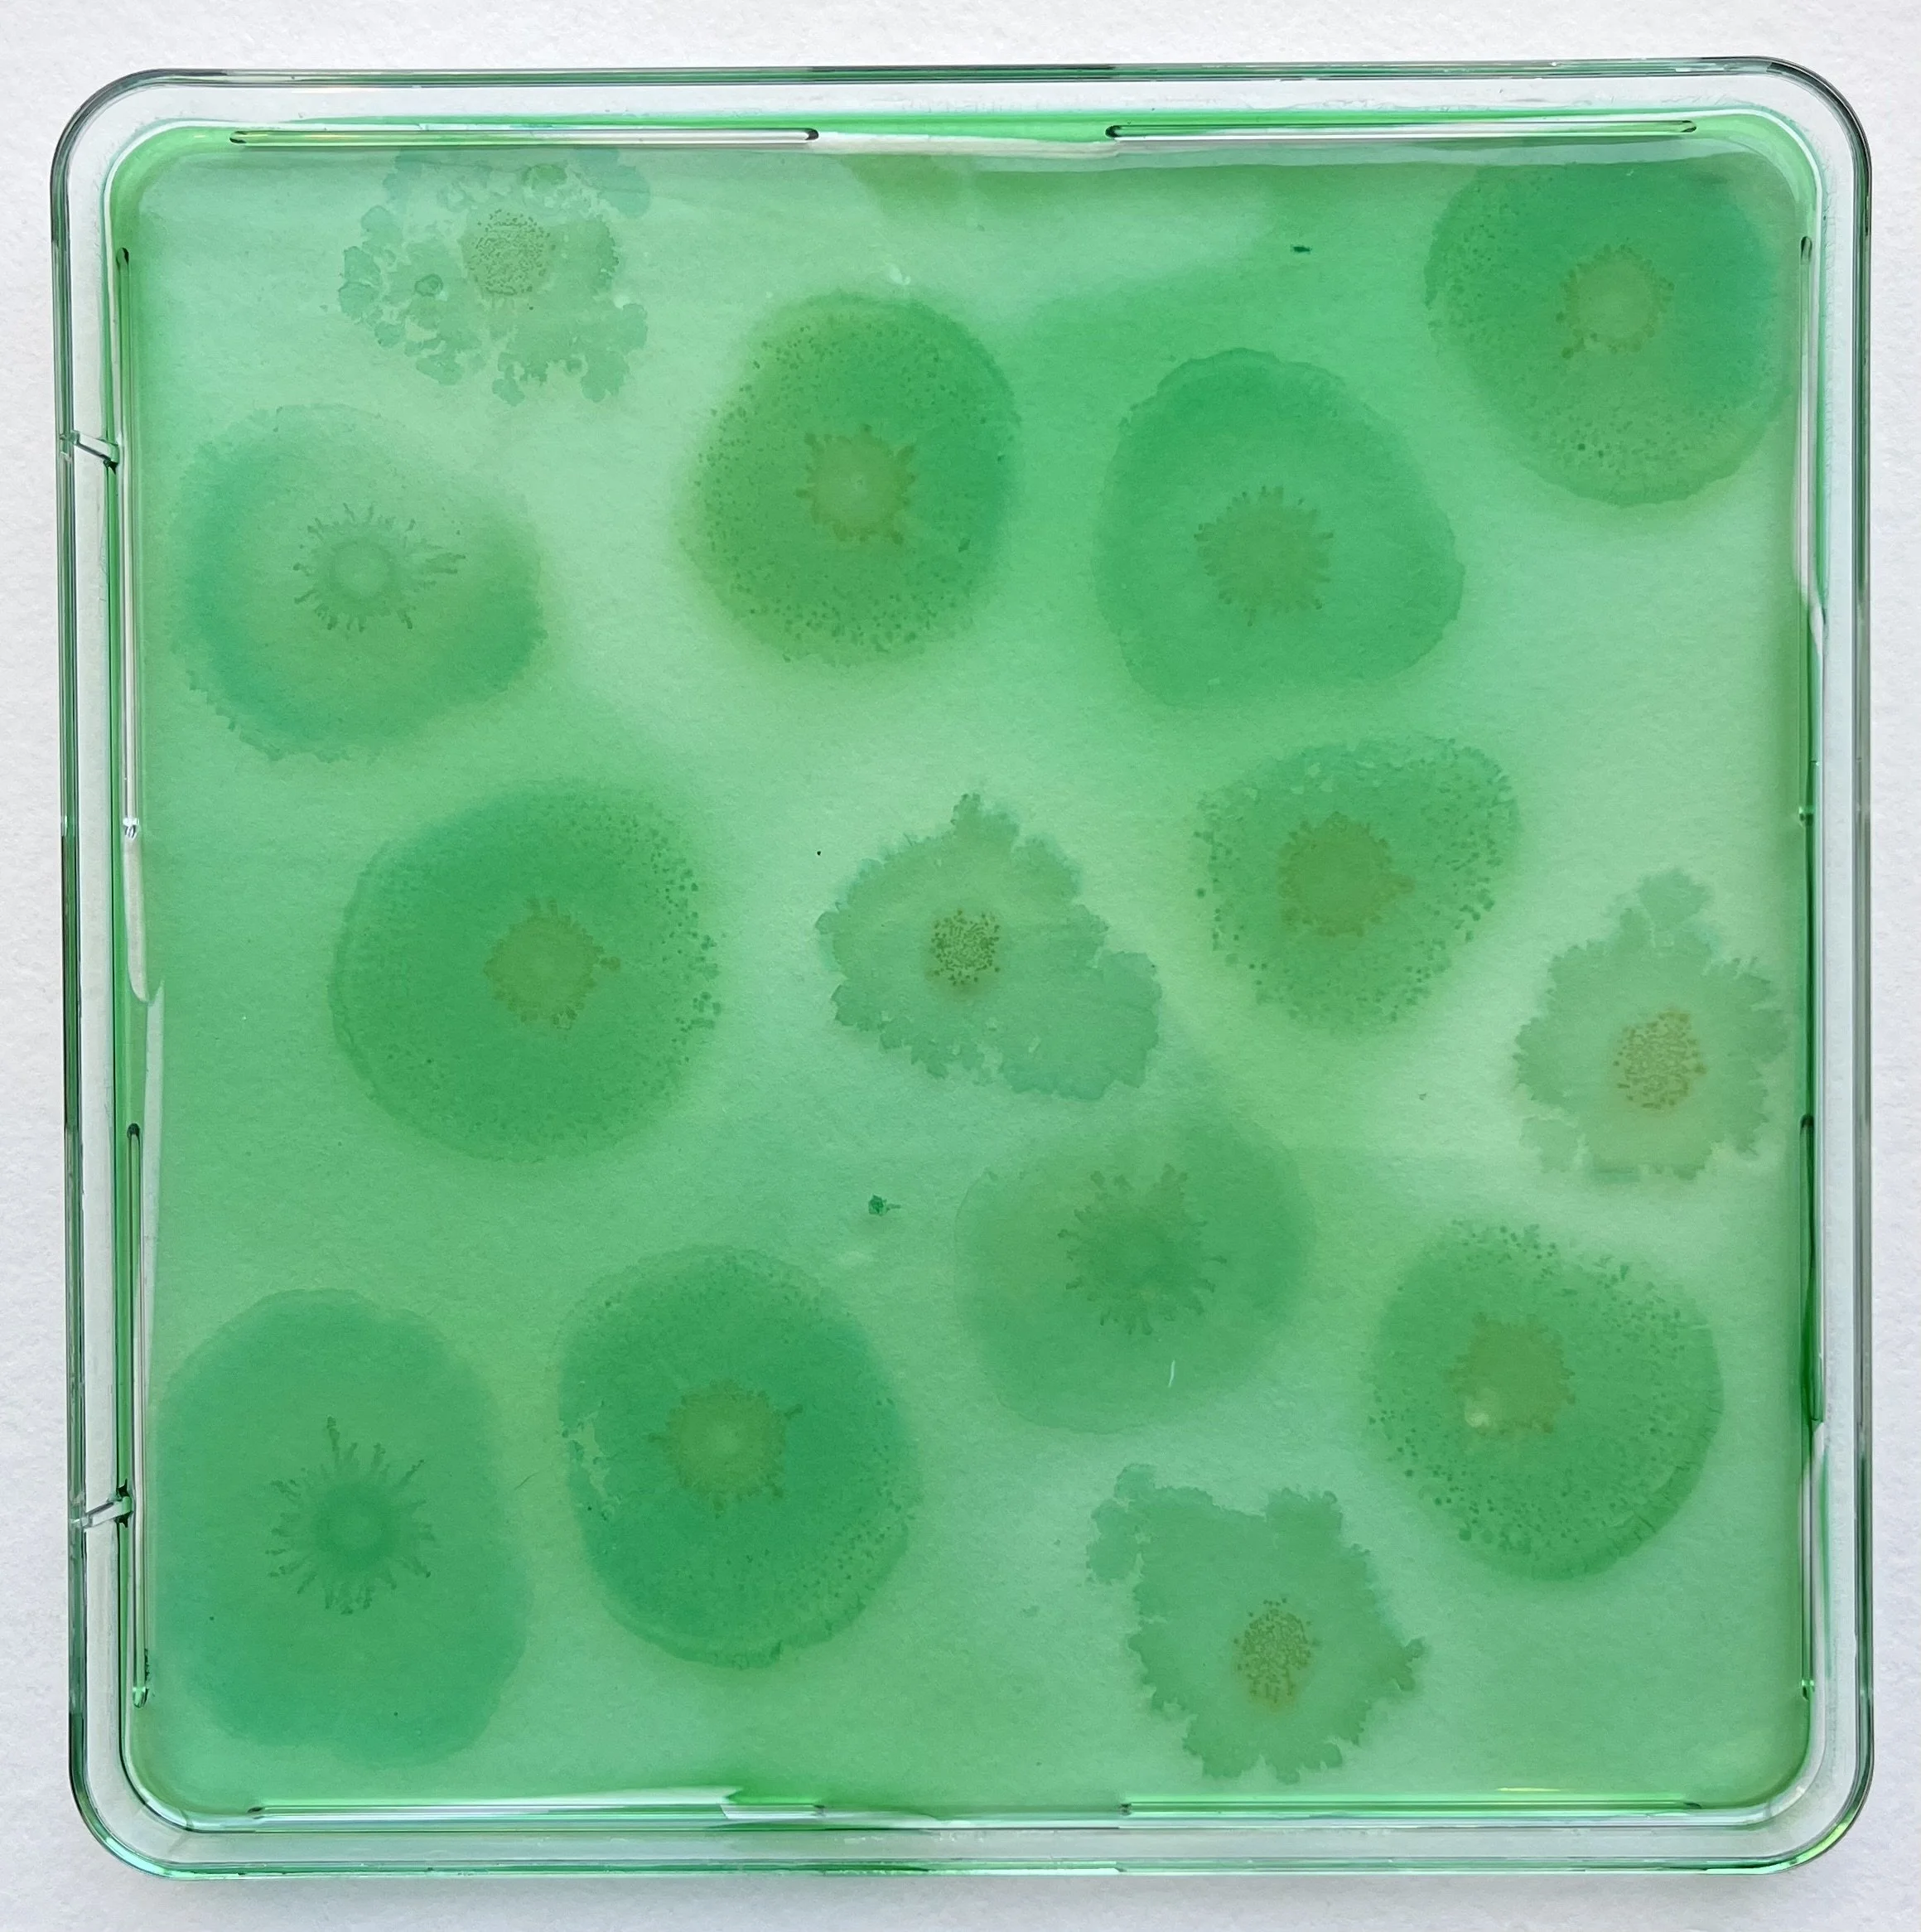
t4.4+t2.1+t4.2.jpeg
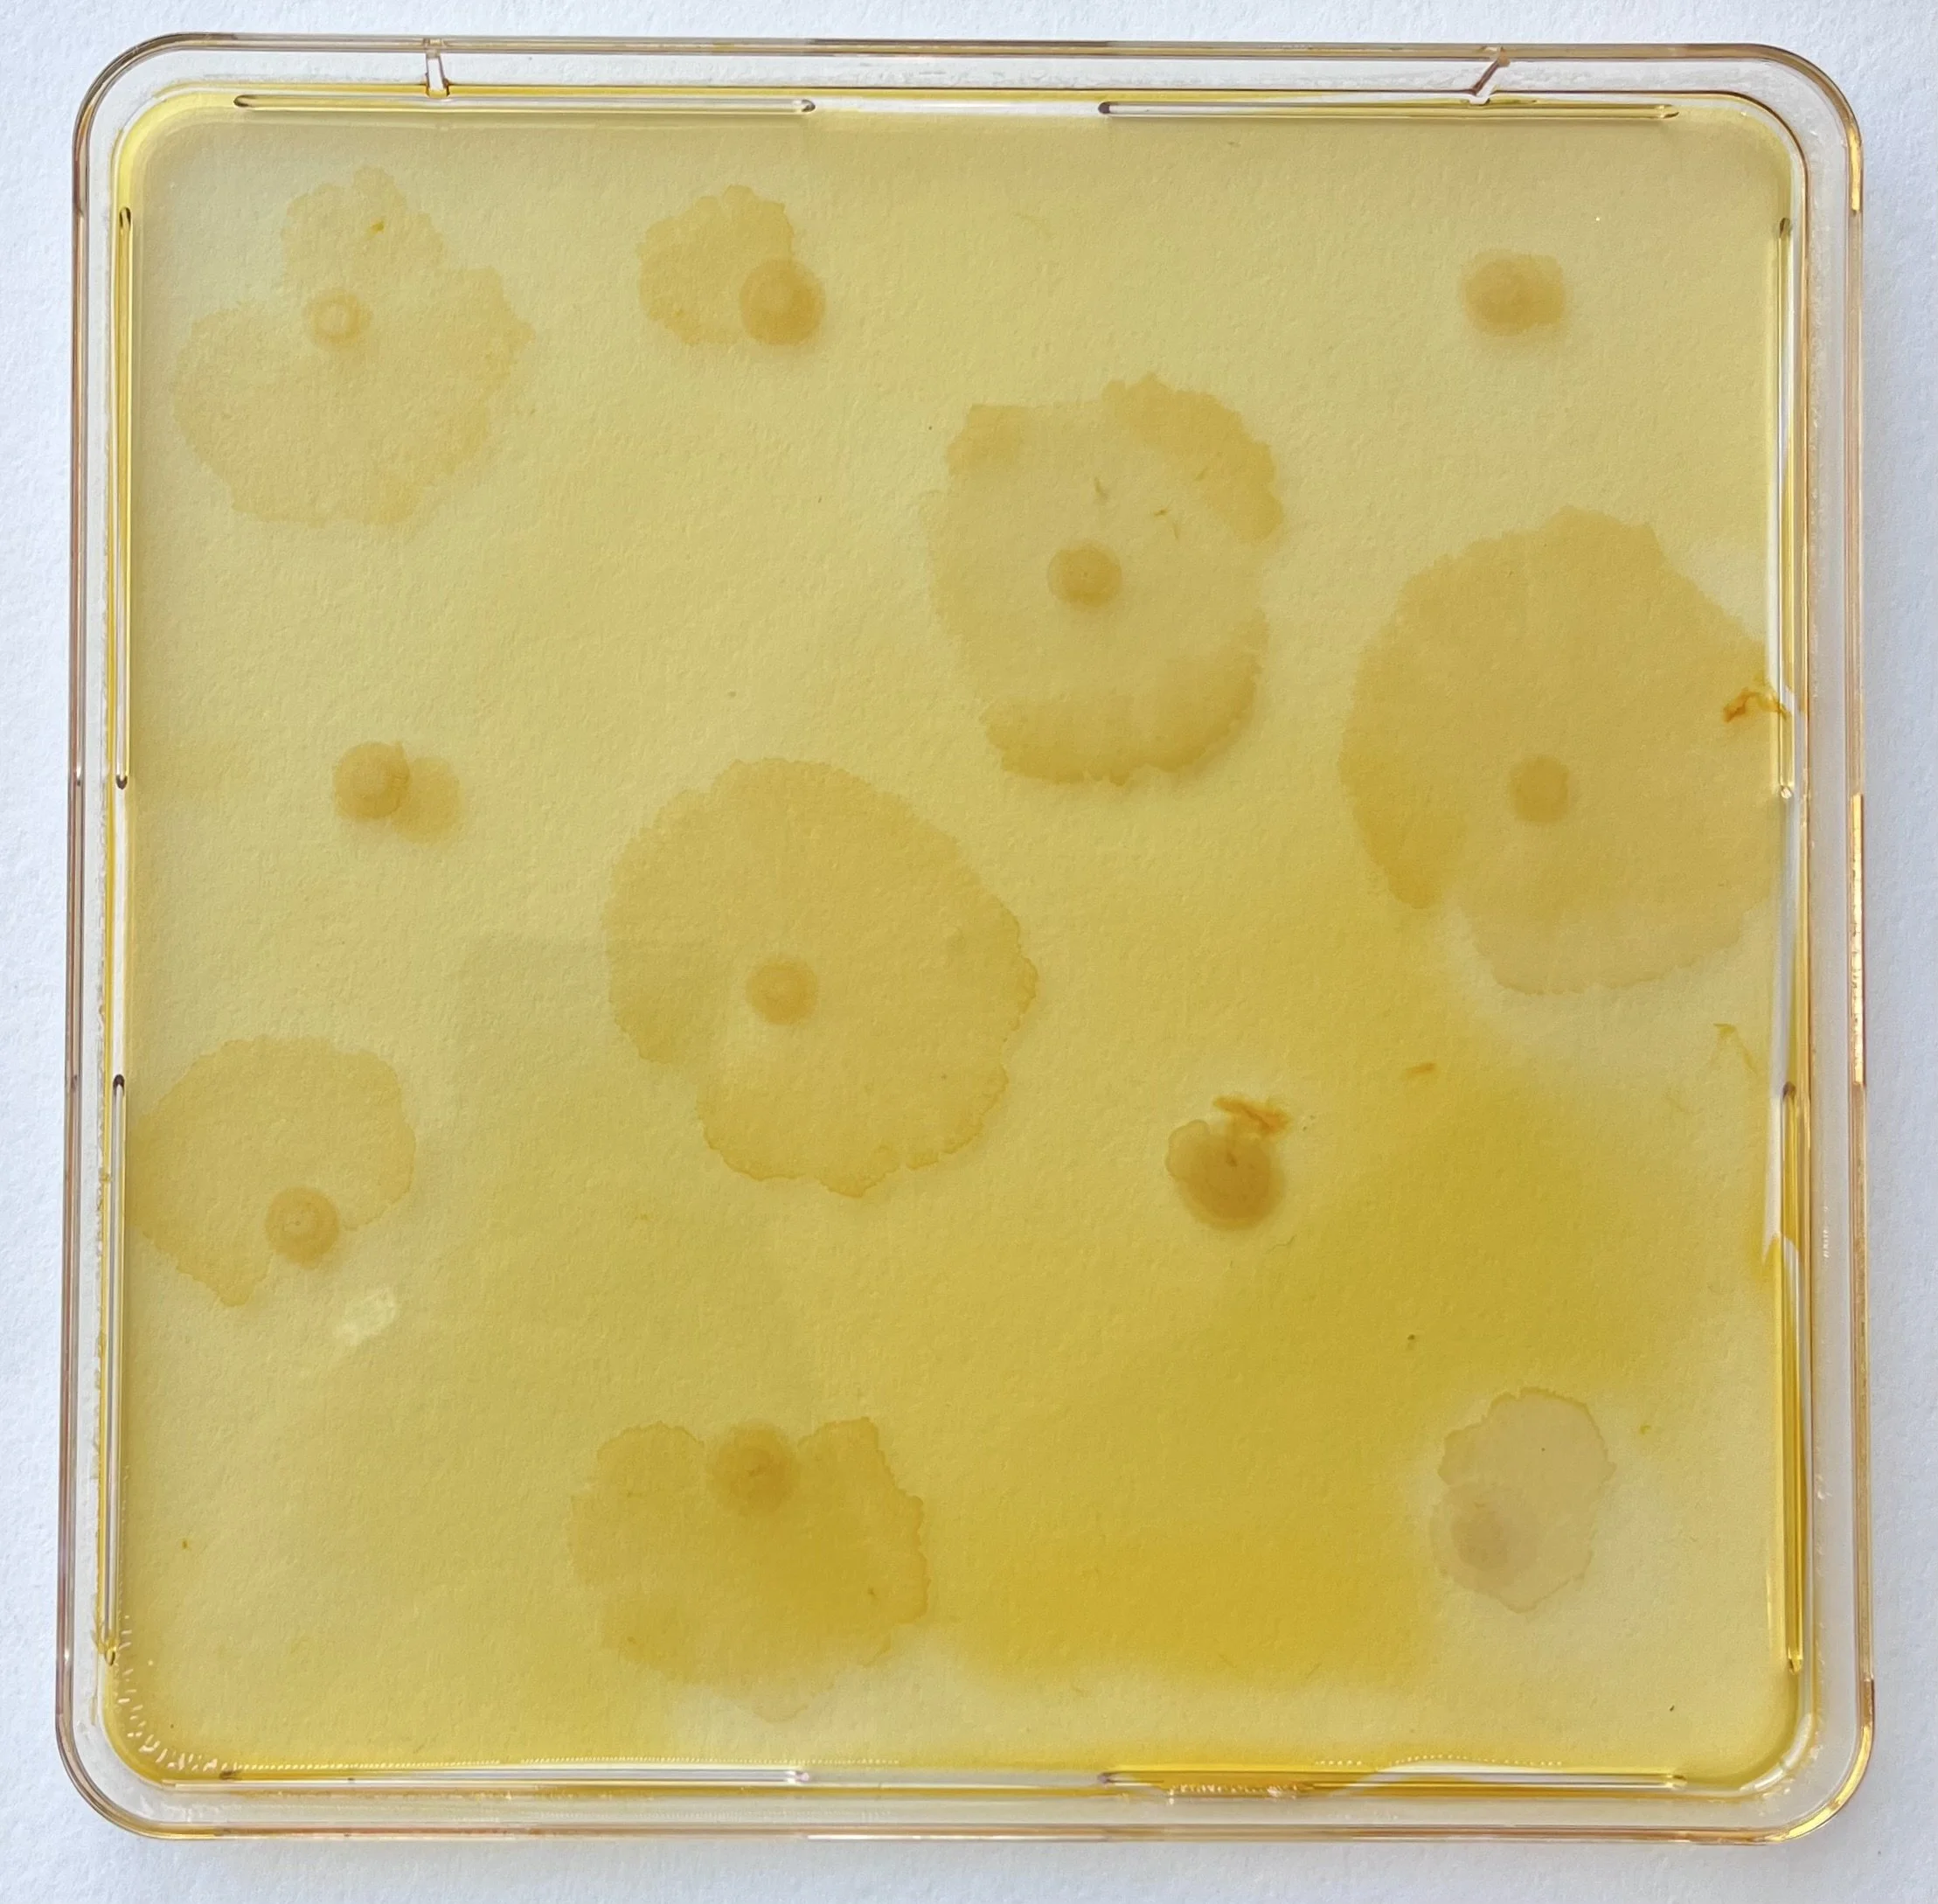
t1.1.jpeg
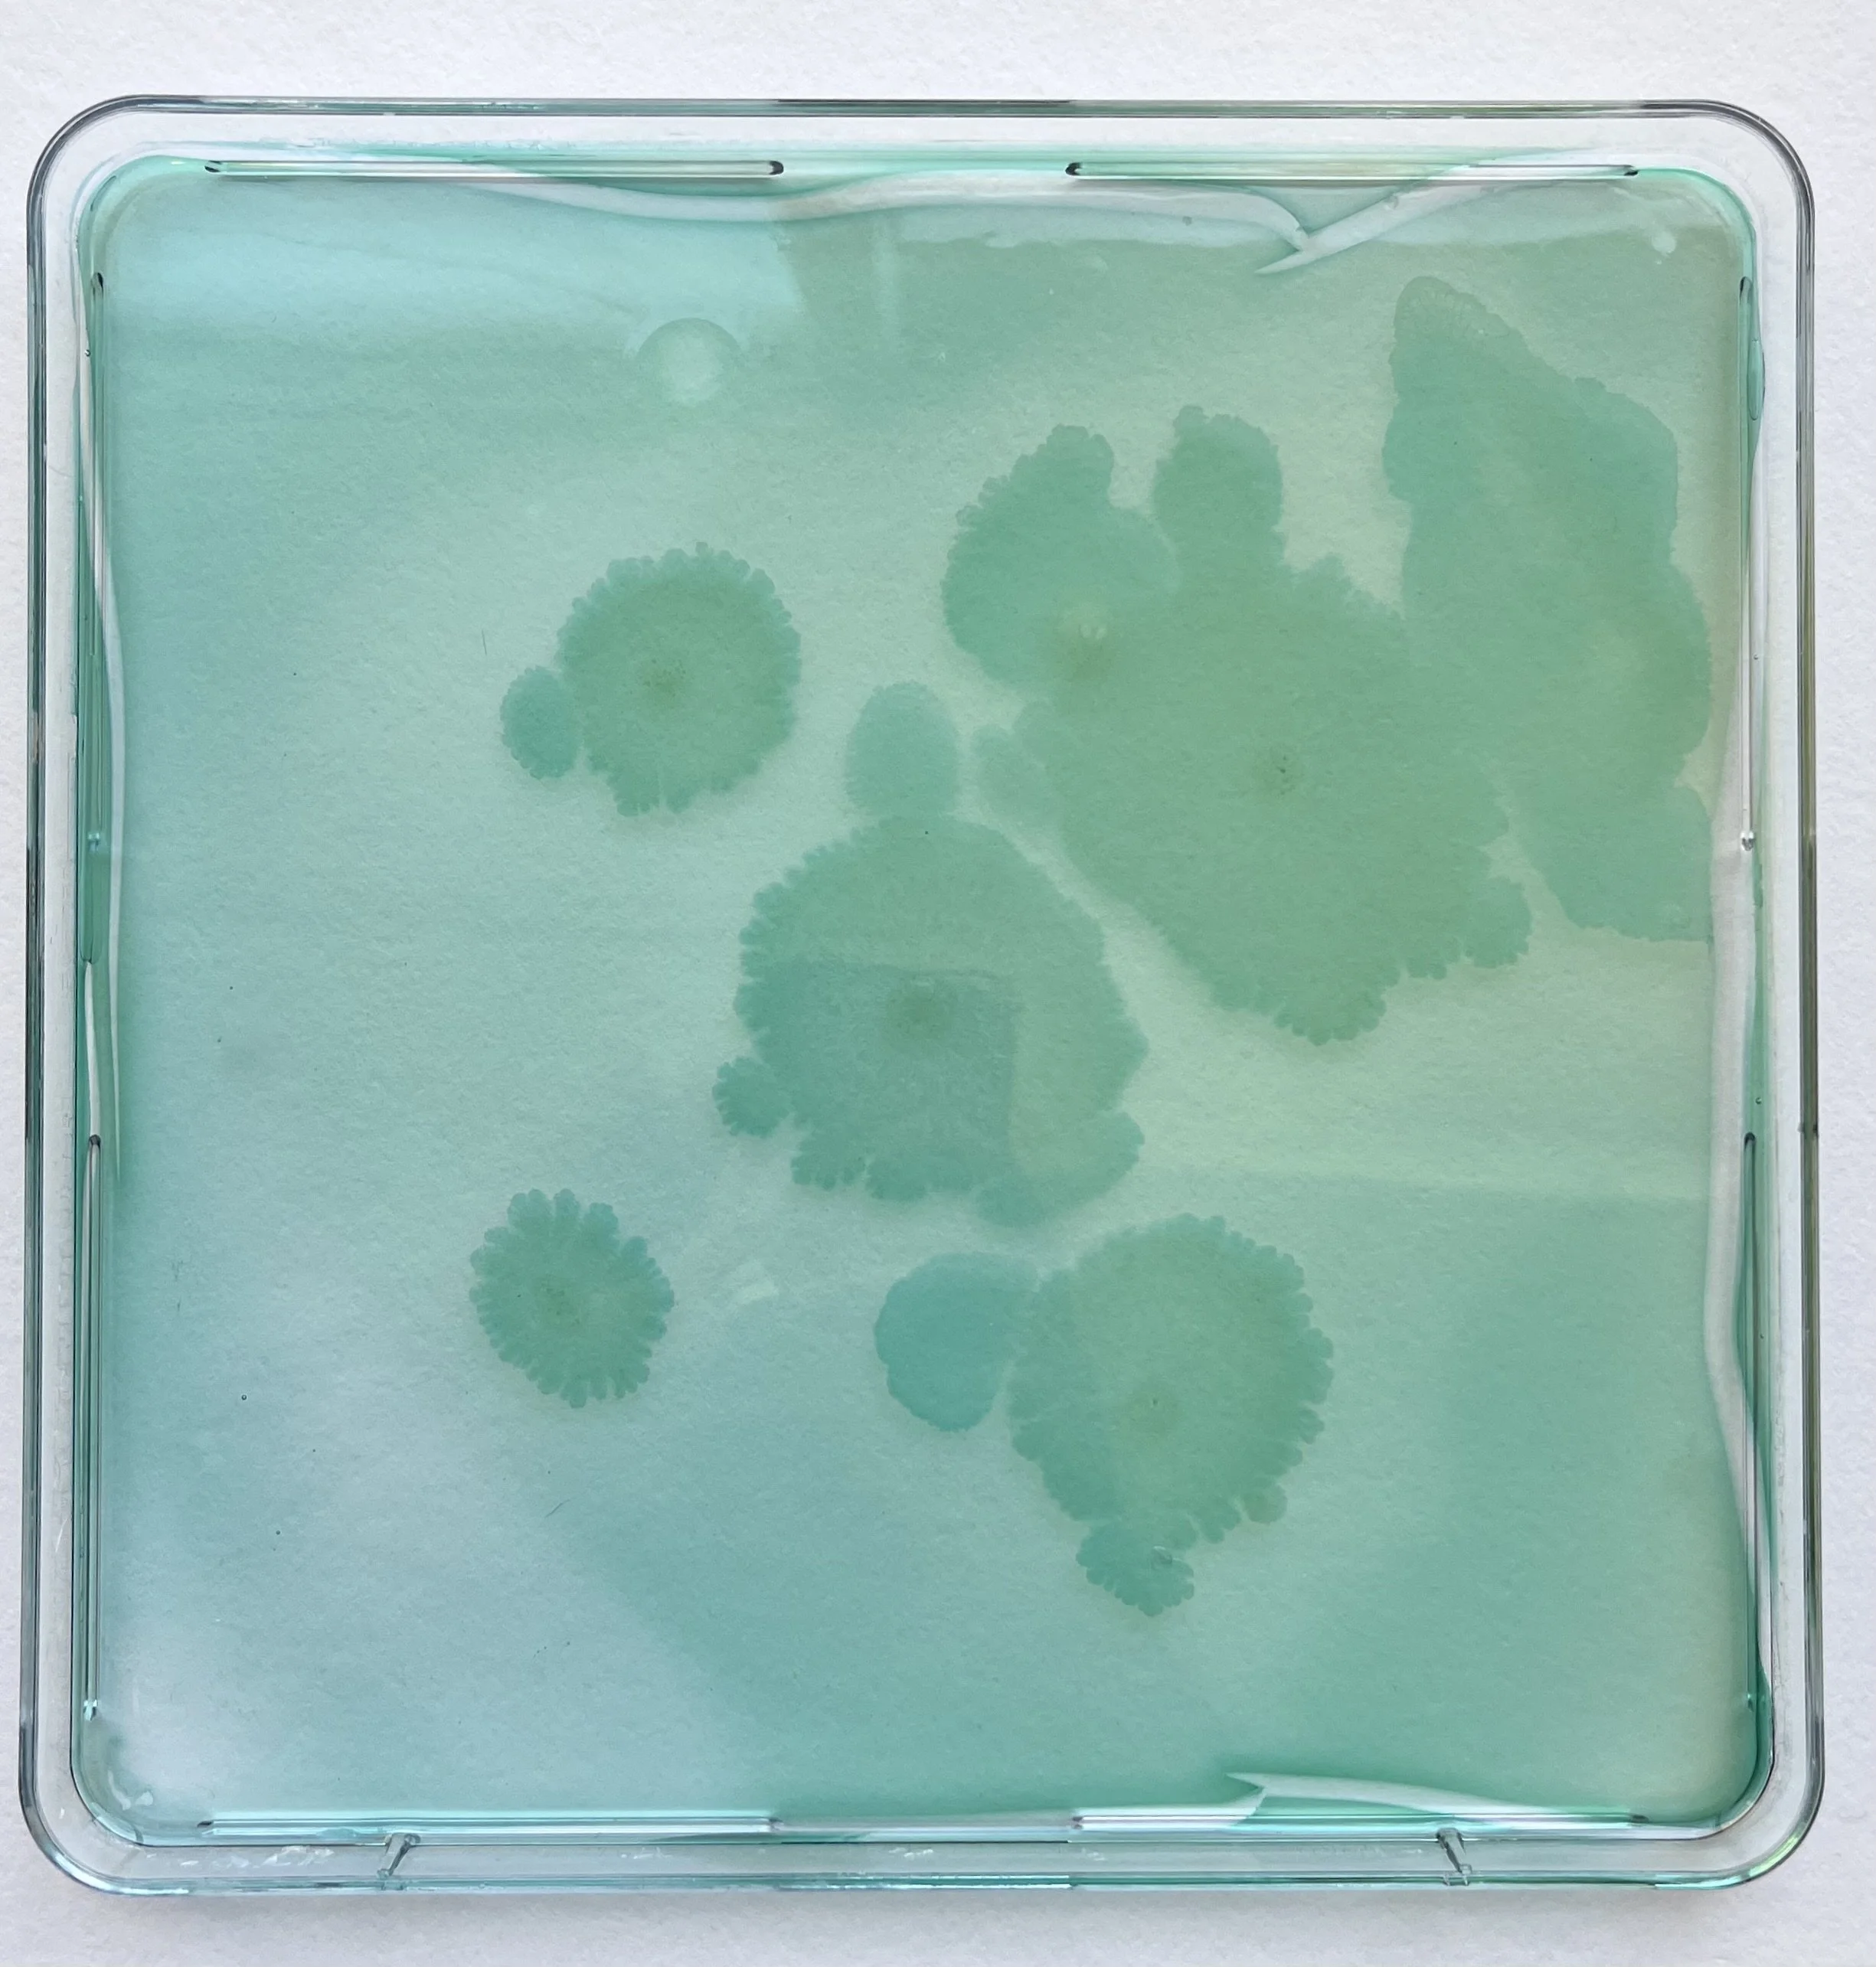
f1.4.jpeg
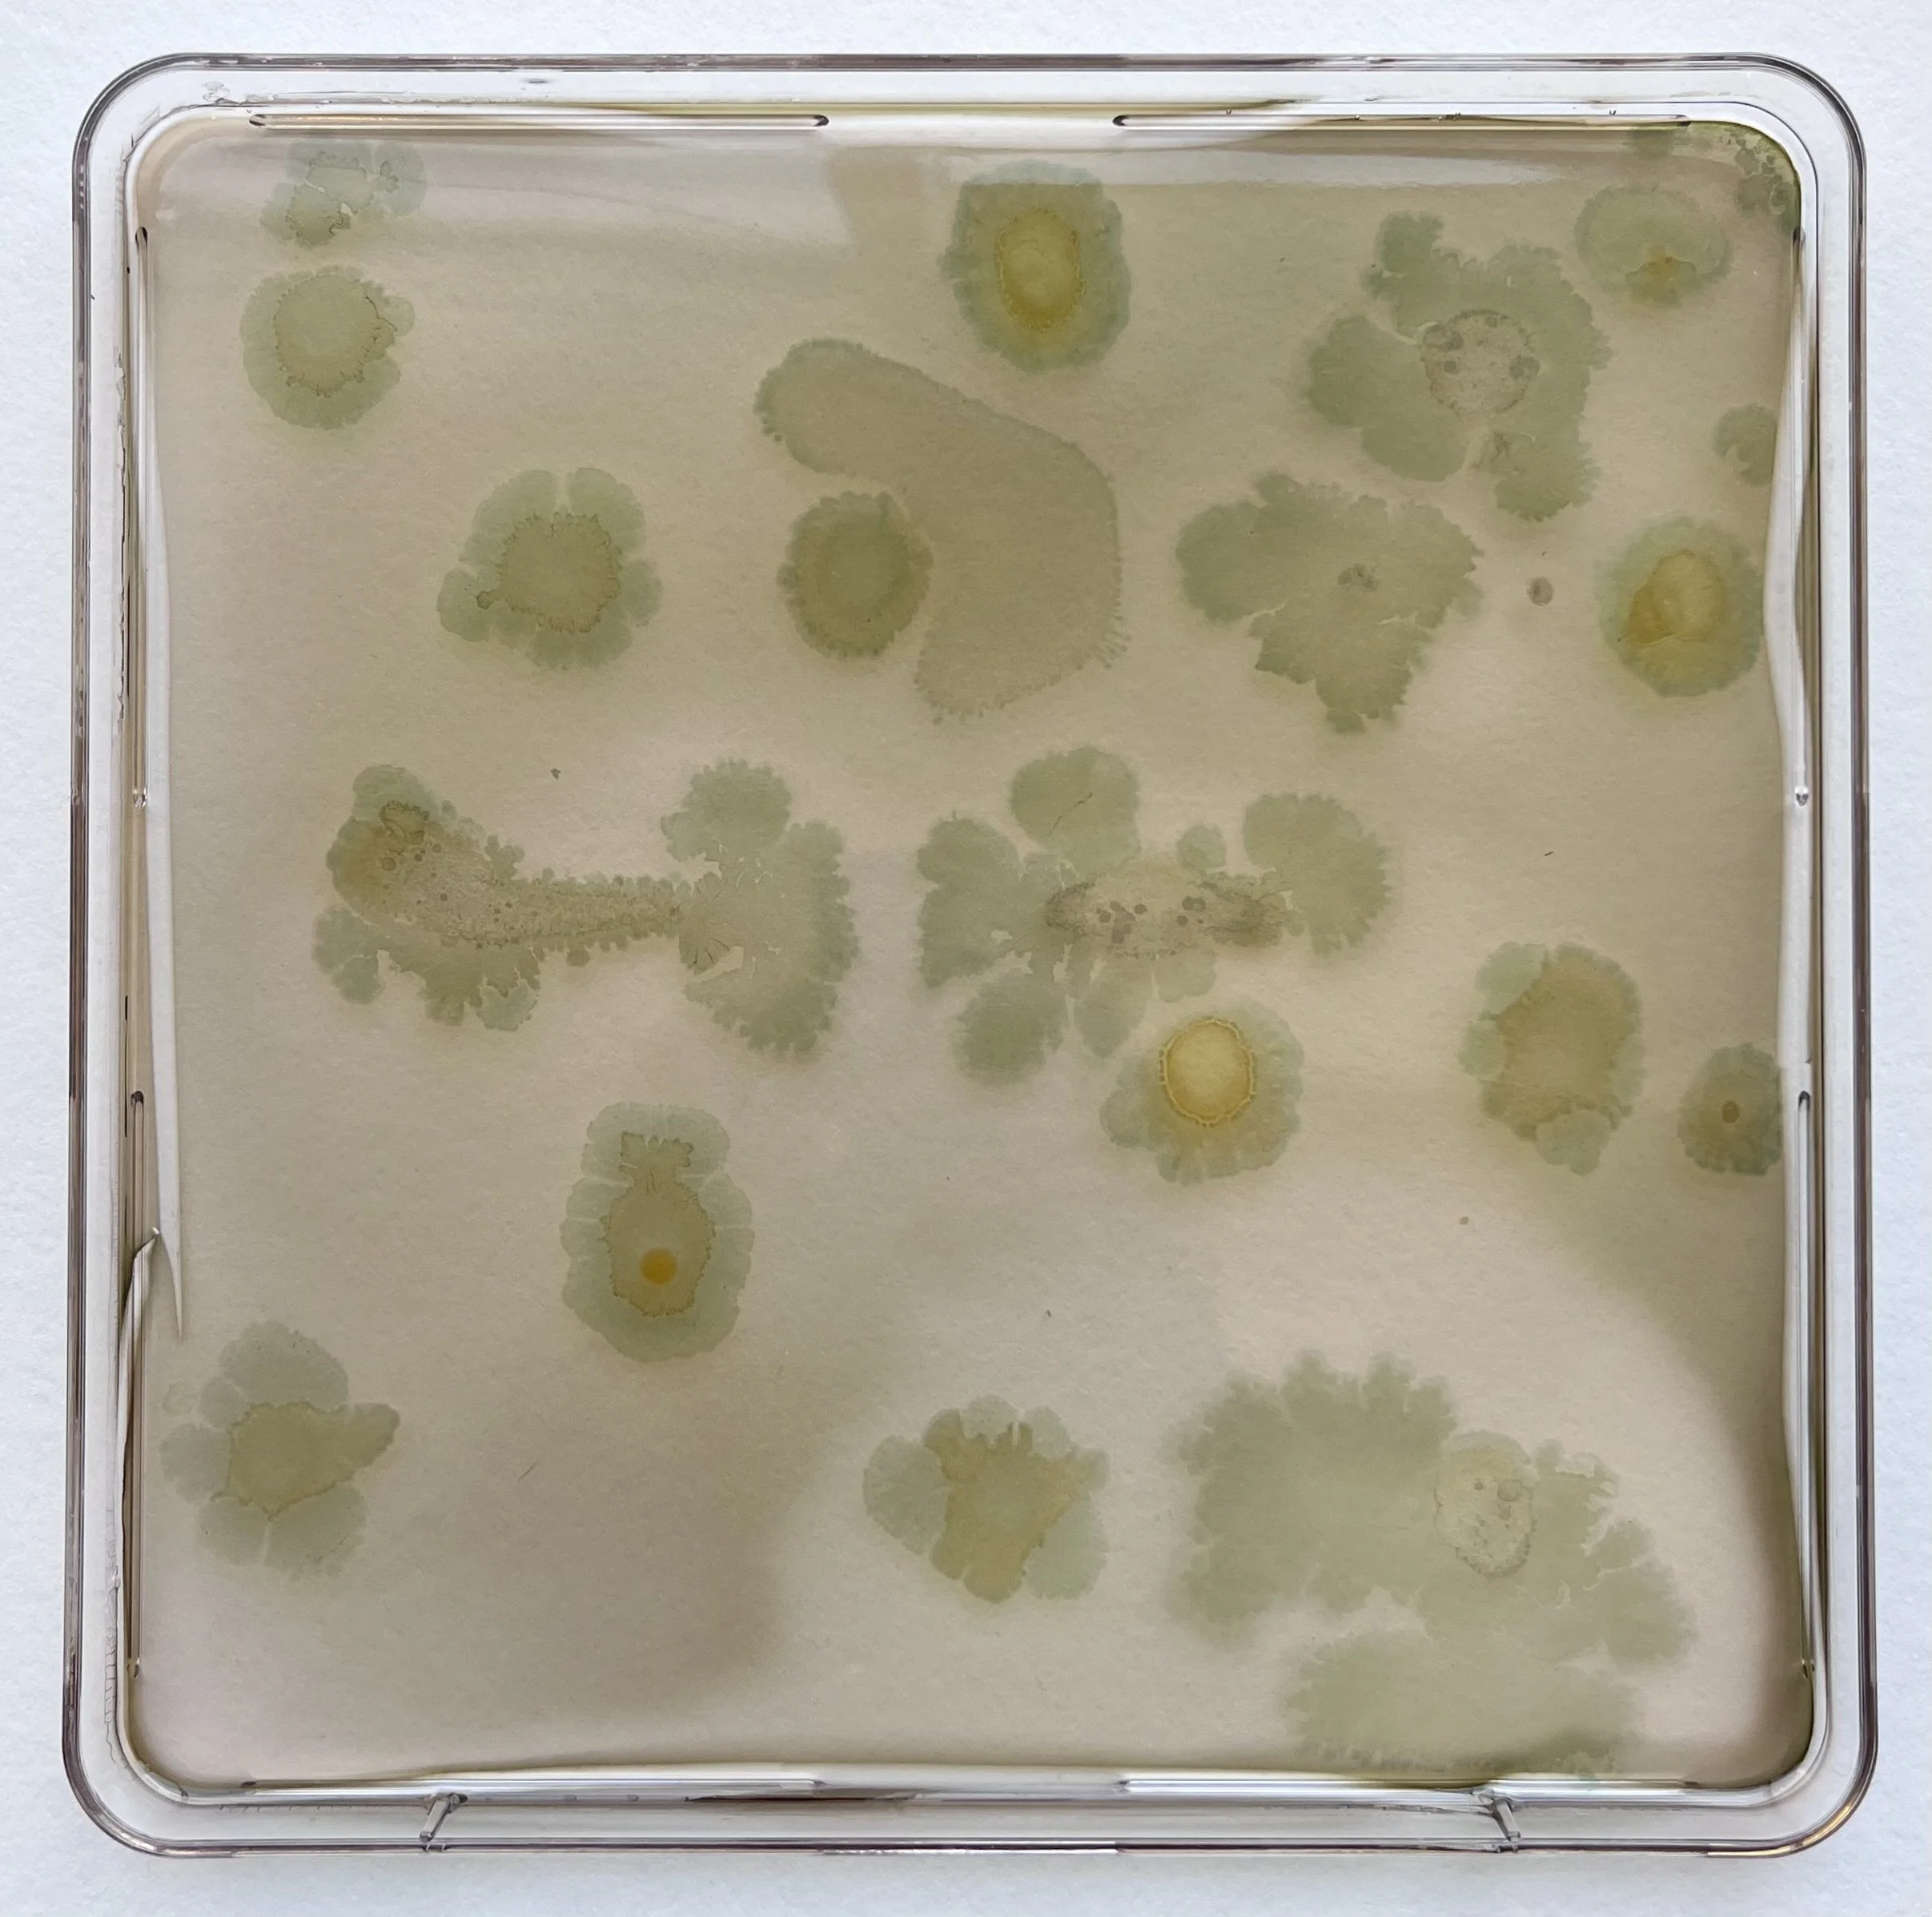
f1.5+f4.1+f2.7+f1.3.jpeg
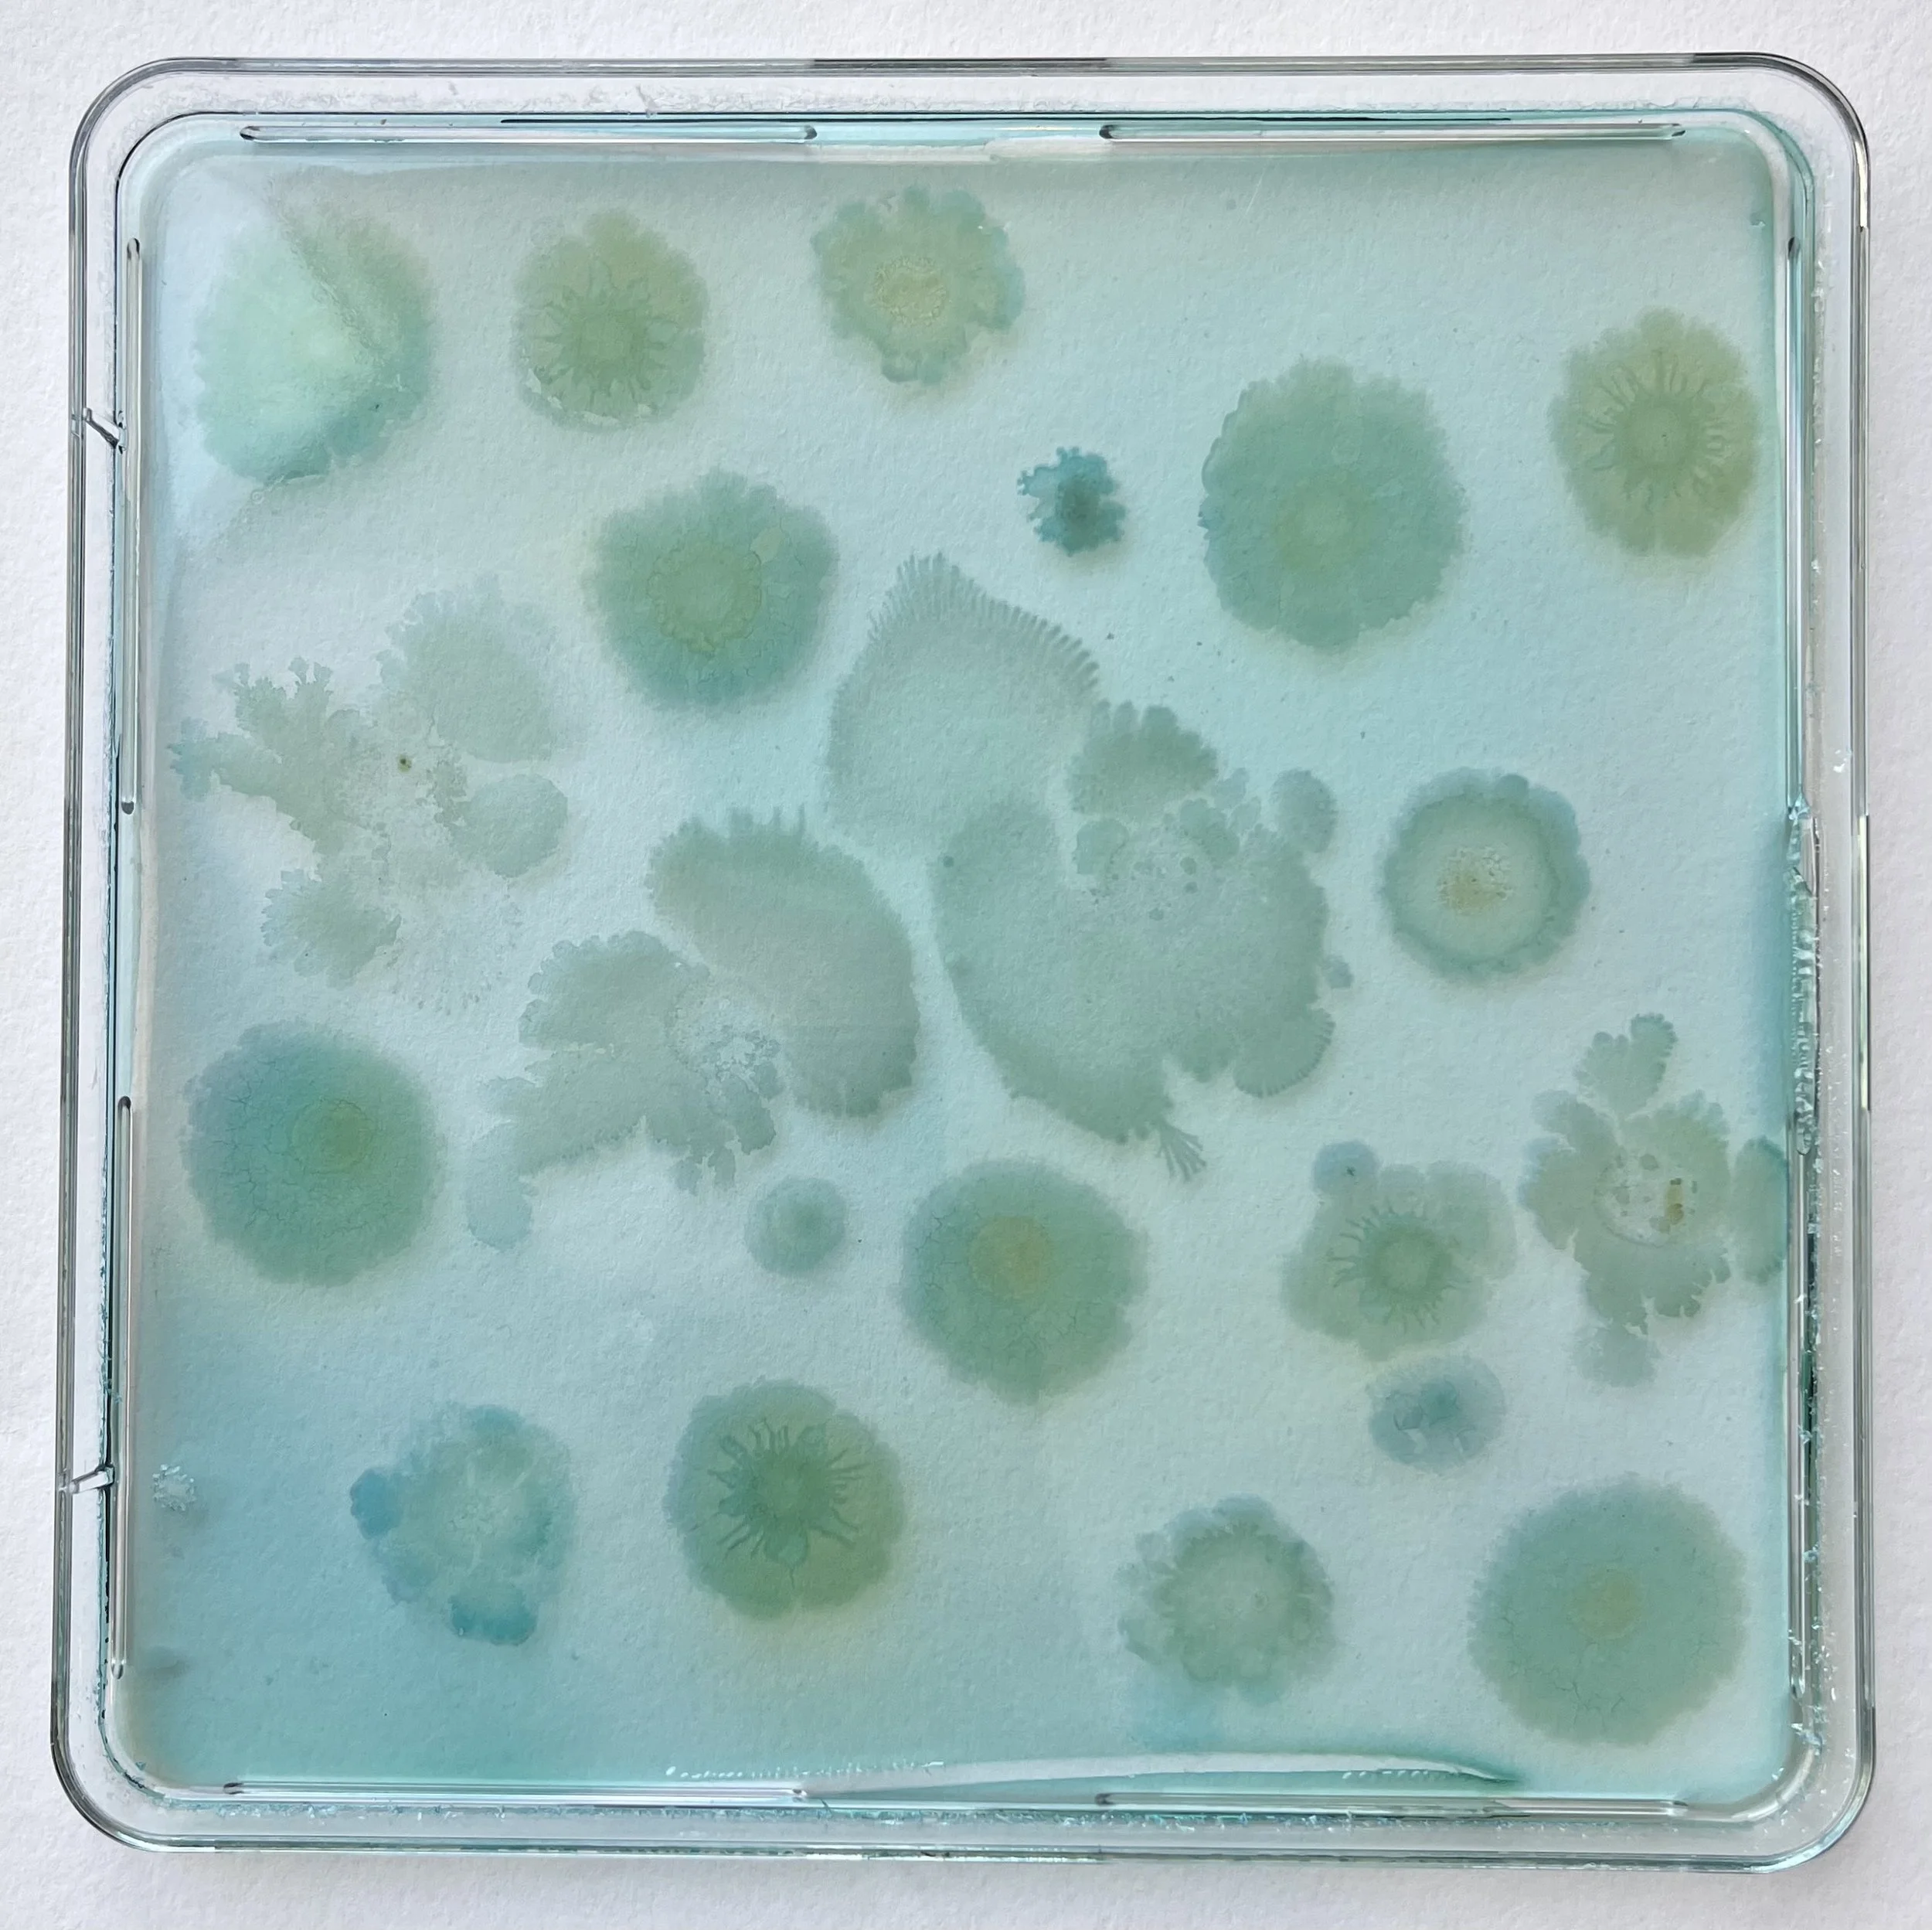
f2.2+f1.1+f1.2+f1.3.jpeg
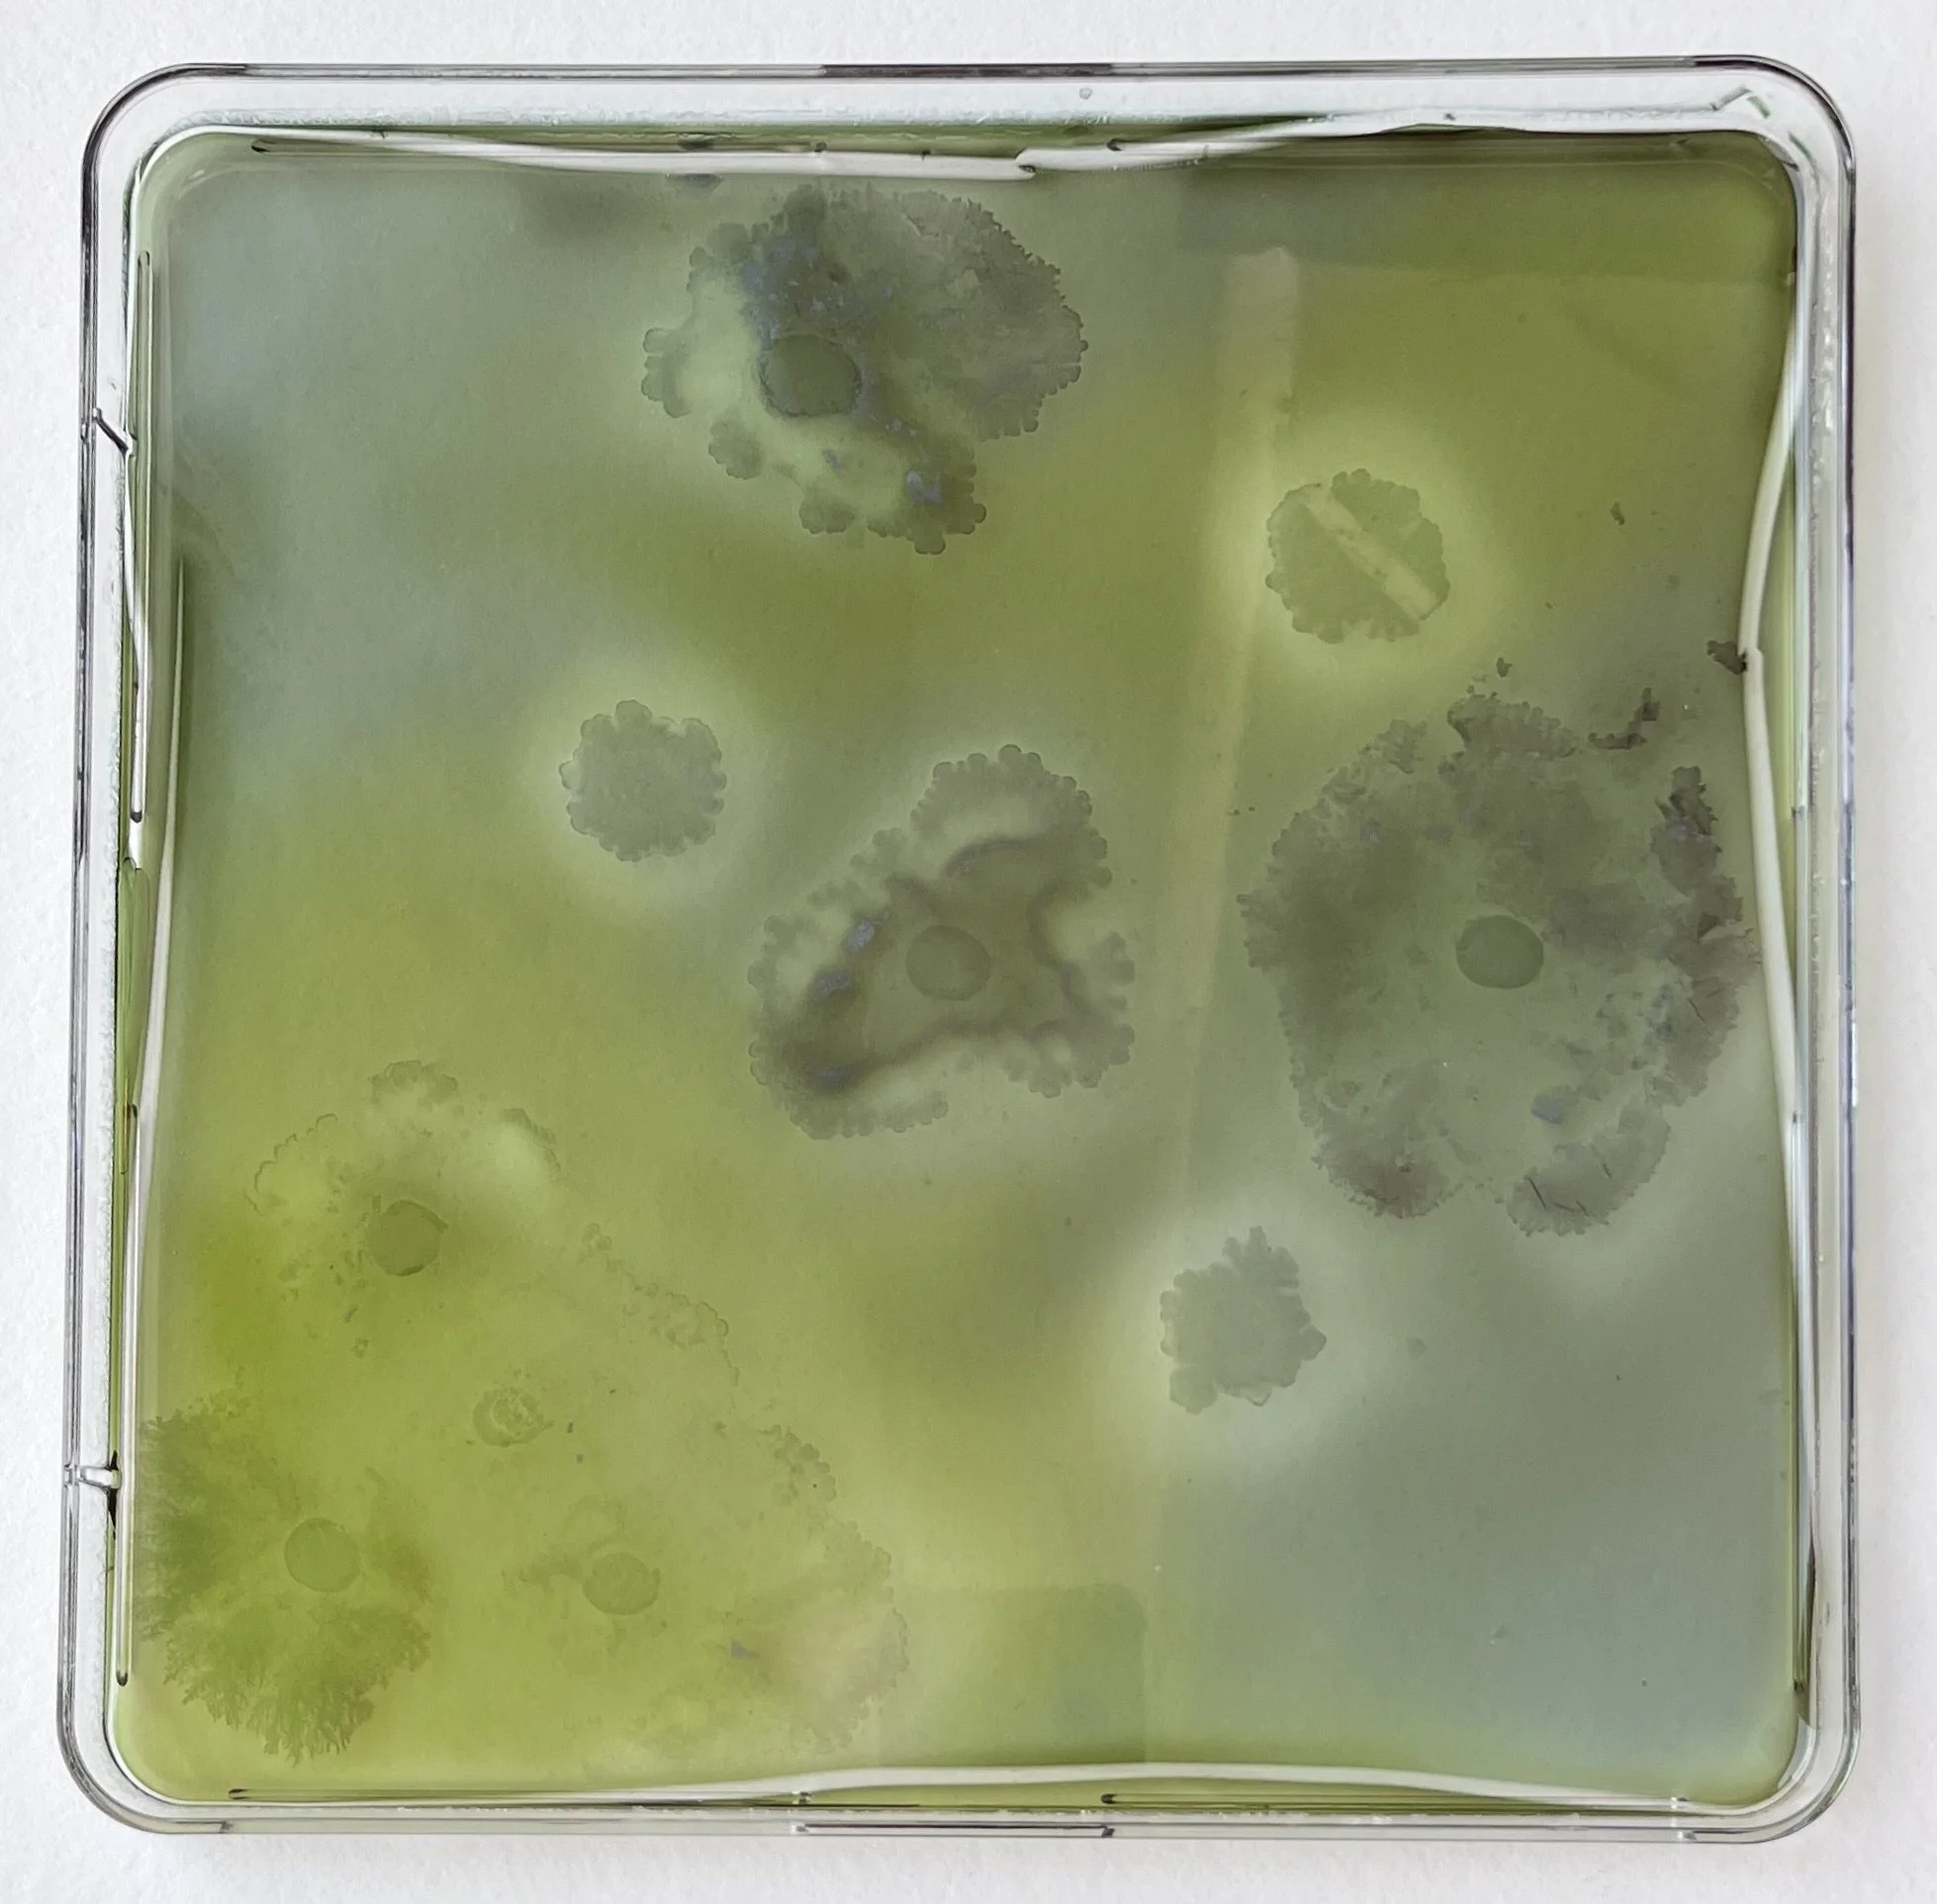
f4.4+f4.2.jpeg
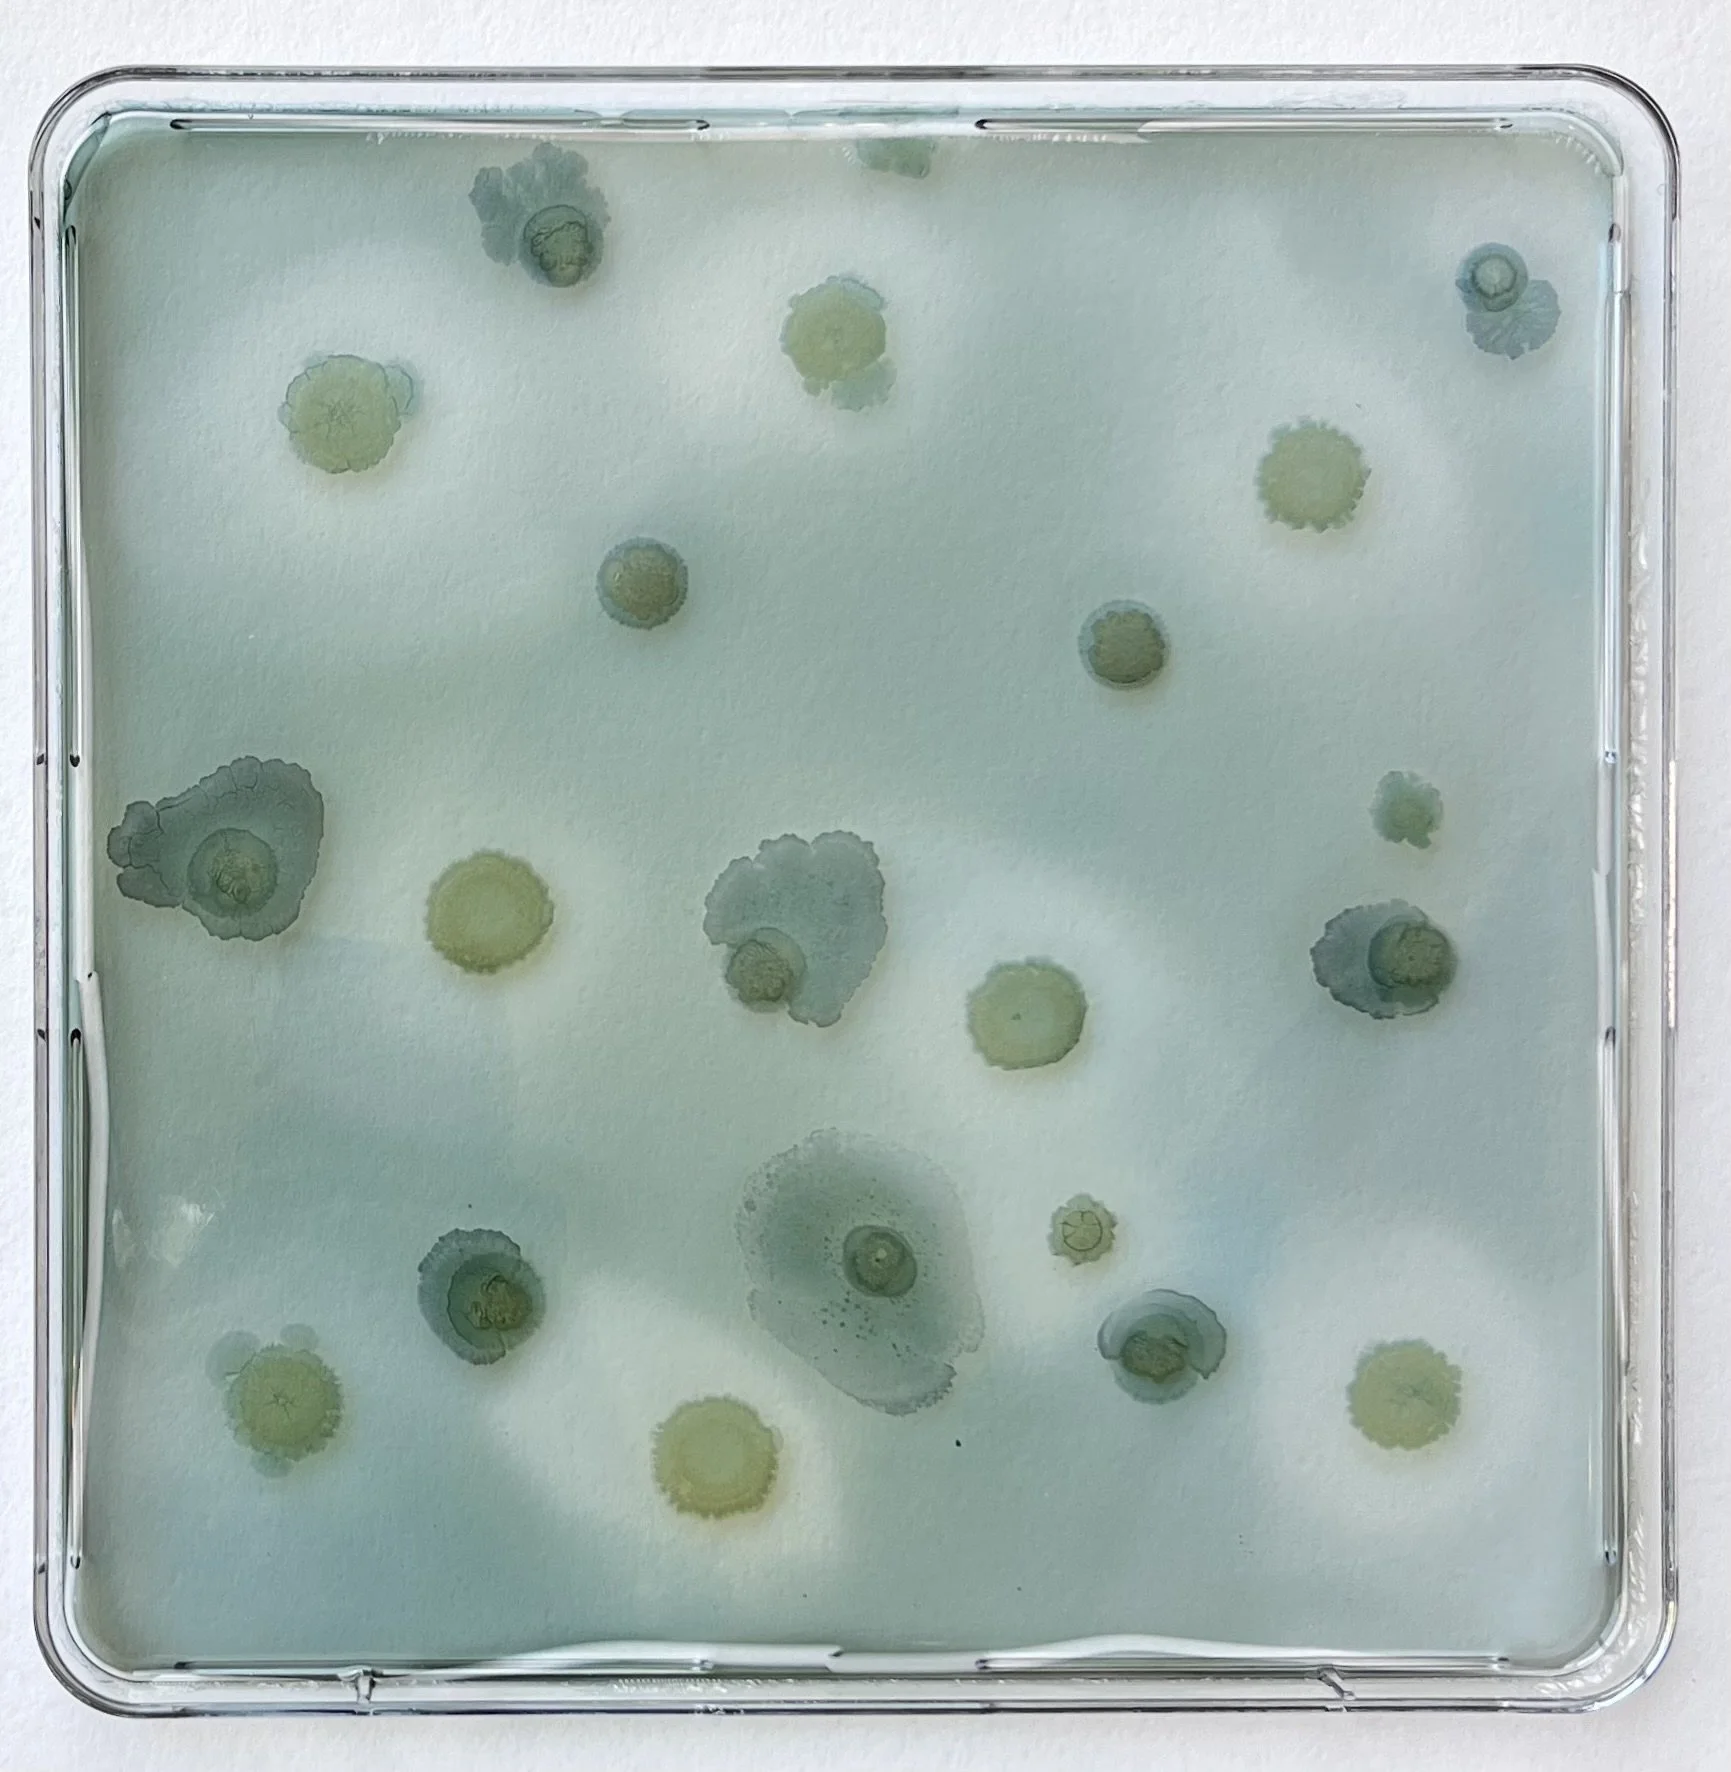
t1.1+t1.4-blue.jpeg
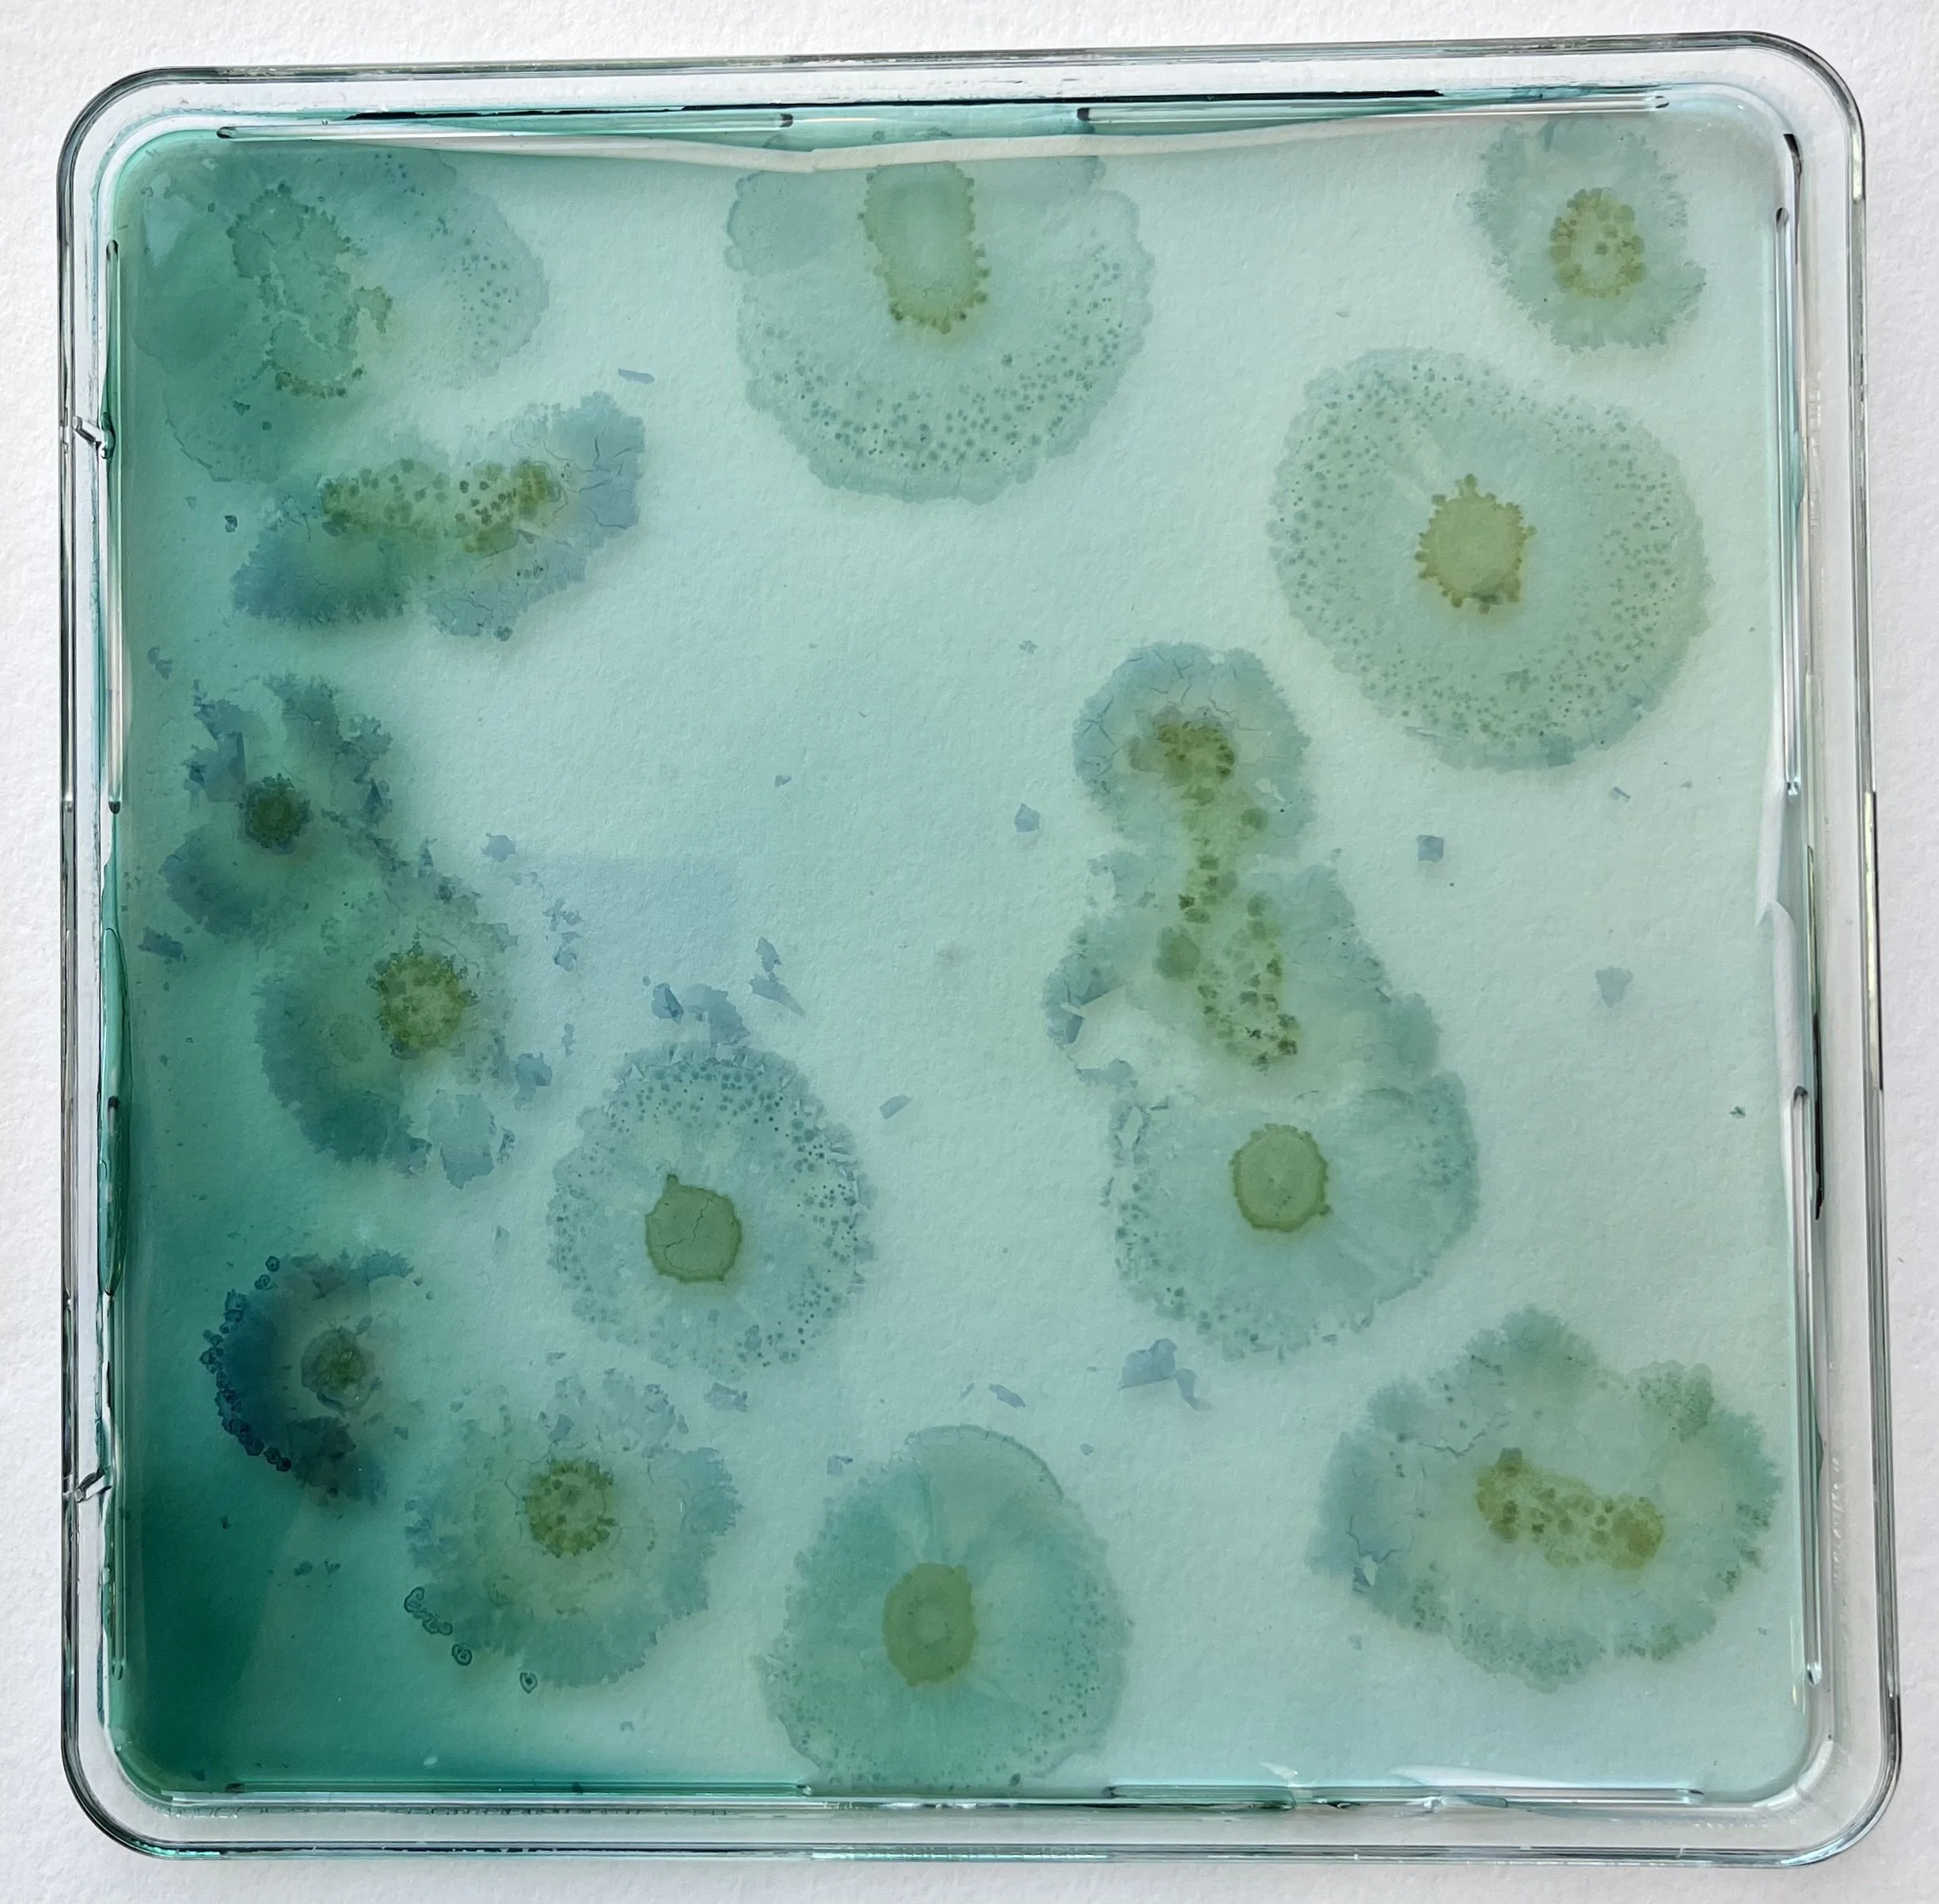
t3.5+t2.1.jpeg

TERRA, 2025
TERRA is composed of two 3x3 panels that capture microbial traces from two distinct landscapes. One is Parco Sempione, an urban park encircling the Triennale building in Milan—its grounds layered with history as a former nineteenth-century parade field. The other is the Bosco di Riazzolo, a protected woodland south of the city, where native plant and animal life have endured since the area served as a medieval hunting preserve. The flora that sustains this soil today echoes descriptions found in Virgil’s ancient poems, written over two millennia ago.
Soil samples from both sites were cultivated on agar, revealing a vivid unfolding of microbial behavior. Colonies bloomed in intricate formations—some growing until they met and intertwined, others halting at invisible borders, forming stark zones of repulsion. These interactions mapped a dynamic network of cooperation, competition, and spatial negotiation. By staining the colonies and sealing them in resin, these fleeting biological expressions are preserved—offering a glimpse into the quiet vitality that thrives just beneath the surface.
TERRA invites reflection on the human role in shaping microbial ecologies. Differences in bacterial diversity between the park and forest were striking, with the latter showing richer, more varied growth. This contrast speaks to the lasting imprint of human intervention—through conservation, expansion, or neglect. In making the invisible visible, TERRA reveals the living architectures we continuously influence through our presence on the land.
In 2025, TERRA was exhibited at We the Bacteria: Notes Towards Biotic Architecture as part of the Triennale di Milano’s 24th International Exhibition Inequalities in Milan.